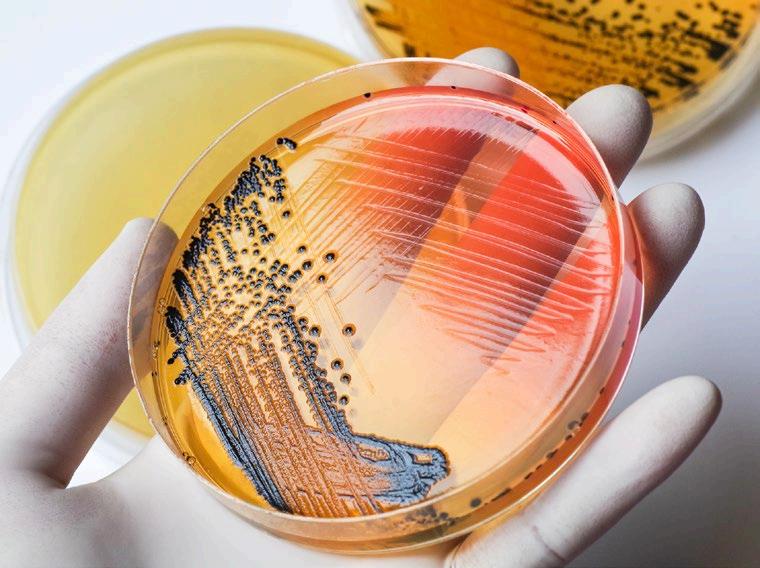
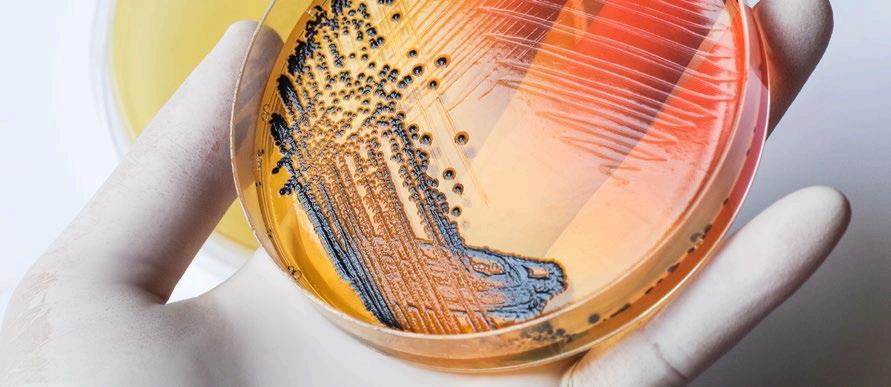

¡Bienvenidos al aviFORUM-PUESTA AVINEWS, el evento de referencia de la avicultura de puesta!
Tras el espectacular éxito obtenido en el aviForum Puesta del año pasado celebrado en la ciudad de San Sebastián tanto por el número de asistentes como por el interés que obtuvieron los temas tratados por los distintos ponentes. El nivel para conseguir igualar esas Jornadas se veía en principio complicado por la organización, pero ahora con todo preparado podemos confirmar que va a ser otro excepcional AviForum Puesta aviNews y que además se va a desarrollar en Córdoba, una de las ciudades más maravillosas de España.
Todo este esfuerzo suplementario de trabajo ha sido efectuado por el equipo para mantener la confianza de todos los profesionales en el Evento técnico y social de la Avicultura de Puesta en España y Portugal y que puedan asistir a él con toda la confianza y seguridad de obtener un buen rédito a su tiempo.
Cómo entendemos desde la organización, que nuestro sector avícola de producción se nutre del intercambio de conocimientos y del planteamiento de dudas y retos. Vistos los comentarios del año pasado, el aviFORUMPUESTA vuelve a presentarse con un formato renovado donde los grandes debates y las mesas redondas ganan protagonismo. Con este formato, seguimos intentando incrementar la interactividad de los asistentes con los ponentes del evento y viceversa, con el fin de ofrecer al congresista unas Jornadas que le sorprendan, le motiven y le haga aumentar sus conocimientos y su red de contactos.
Debates que cuentan con los mejores profesionales para comentar sus conocimientos y para contestar las preguntas y dudas de los asistentes.
La organización de estas Jornadas supone cada vez un mayor reto por el elevado número de encuentros profesionales existentes. Por ello, es una mayor satisfacción y orgullo, conseguir reunir un elenco tan numeroso de grandes especialistas junto a Propietarios de explotaciones, Directores de Producción, Veterinarios y Técnicos vinculados a la avicultura de puesta.
Indudablemente el éxito del AVIFORUM-PUESTA sólo tiene lugar gracias a la participación y colaboración de los ponentes, que se han esforzado y a veces hasta anticipado a las necesidades de la organización, para tener toda la documentación que se les ha solicitado en los tiempos previstos. Pero especial agradecimiento hay que efectuar a los Patrocinadores del AVIFORUM- PUESTA AVINEWS, sin cuya participación hubiera sido imposible haber llevado a término la organización y el desarrollo de estas Jornadas sobre la avicultura de puesta.
¡Gracias por vuestra colaboración!
La organización Grupo Comunicación agriNews
08:30 - 09:30
Acreditaciones
09:30- 10:00
Inauguración

Luis Carrasco
Managing Director Grupo de Comunicación agriNews
Bloque 1 – Nutrición y Calidad del Huevo
10:00 - 10:15
El control del peso y el tamaño del huevo en ponedoras comerciales de acuerdo a las preferencias de mercado


José Luis Valls
Director Técnico AviNews España
Reza Akbari

Moghaddam Kakhki
Poultry Nutrition Research
Scientist Poultry Research
Centre Trouw Nutrition
Estrategias nutricionales para mejorar la calidad del huevo y la extensión del ciclo productivo de la gallina ponedora
Calcio en acción: transformando el metabolismo óseo y fortaleciendo la cáscara del huevo
Diálogo entre expertos: Nutrición y calidad del huevo

Joel Estevinho
European Poultry Technical Manager en Alltech

Julio Díaz
Berrocoso, PhD
Gerente Técnico I+D Avicultura de Tecnovit - FARM FAES
Bloque 2 – Nutrición y sostenibilidad avicultura puesta
La huella de carbono y la alimentación y nutrición de ponedoras
Importancia de la conformación corporal de las gallinas para optimizar los parámetros productivos en puesta
Diálogo entre expertos: Nutrición y calidad del huevo


Jon de los Mozos

Technical Manager Poultry en Nutreco Iberia

Diego García
Poultry Technology Application
Specialist Cargill
Bloque 3 – Bioseguridad en avicultura de puesta
12:45 - 13:00
13:00 - 13:15
Bases prácticas para la bioseguridad en granjas avícolas de postura
Ácido hipocloroso: desinfectante inocuo e higienizante con efecto bioestimulante que mejora la productividad de las aves

David García Páez
Consultor internacional en Bioseguridad

Grégoire Gaume
Director Técnico
Aquactiva Solutions SL
13:15 - 13:30 16:15 - 16:30 16:30 - 16:45 14:00 - 16:00
La nueva era en la desinfección del agua en granjas de puesta

José Antonio Martínez
Ingeniero de desarrollo e investigación en ORPNovatio y BIODYNA SL
Diálogo entre expertos: Bioseguridad en granjas avícolas
Bloque 4 – Actualizaciones del manejo en sistemas alternativos
16:00 - 16:15
16:45 - 17:15
17:15 - 18:15
18:15 - 20:00 13:30 - 14:00
Control ambiental en los sistemas abiertos de puesta
Iluminación dinámica multispectral y su influencia en el comportamiento y en la producción de las ponedoras alternativas
Importancia de la recría de pollitas en sistemas de aviarios para mejorar los rendimientos en la fase de producción

Serafín García Freire
Responsable técnico de avicultura en Boehringer Ingelheim. Conferencia ofrecida con el apoyo de CTIControl


Nice Hasani
Business Development
Manager at ONCE Animal
Lighting by Signify IIG& Iberia

Mari van Gruijthuijsen
Business Development
Manager Hellmann
Diálogo entre expertos: Actualizaciones del manejo en sistemas alternativos
5
Los medios de comunicación y su impacto en la imagen social de la ganadería

Fernando Díaz Villanueva Periodista y Divulgador histórico


Con el apoyo de




Las detecciones más avanzadas del mercado para la máxima calidad en la producción Los estándares de higiene más elevados de la industria
Soluciones automatizadas adaptadas exclusivamente a la industria del huevo
Soporte 24/7 durante más de 30 años
09:30 - 10:15
10:15 - 10:30
10:45 - 11:00
Actualizaciones sobre el Mycoplasma synoviae
Casos prácticos de vacunación con vacunas inactivadas de Mycoplasma

Jose B. Poveda Guerrero
Catedrático de Universidad de Las Palmas de Gran Canaria- ULPGC

Sergio Merinero Martín
Agricultural Engineer UPM
11:15- 11:30 11:00- 11:15
11:30 - 11:45
10:30 - 10:45 11:45 - 12:30
Virus de la bronquitis infecciosa (IBV), hallazgos, diagnóstico y soluciones
¿Por qué vacunar frente a Salmonella Enteritidis durante la puesta?
La vacuna viva bivalente de Salmonella en avicultura de puesta
Autovacunas en avicultura: situación actual y ejemplos prácticos

Jordi Serra Martínez
Sales Manager SANVET / Estudio de la Dra. Kathrin Schulze Bernd

Pablo Soler Romero Servicios Técnicos Avicultura España Calier


Uso racional de antibióticos en avicultura de puesta: eficacia y sostenibilidad

12:30 - 13:15
Félix Ponsa
Technical Consultant de avicultura en Elanco Iberia
Ana Fernández, DVM PhD Responsable del Departamento de Autovacunas del Laboratorio veterinario Exopol

Claudio Chimienti DMV – VET&SPHERE Reseau Cristal Francia
COFFEE BREAK
Diálogo entre expertos: Patología en avicultura de postura
Bloque 7 – Avicoloquio: “Toda una vida en el sector”
13:15 - 14:00
Entrevista con José Pedro Sacristán

José Pedro Sacristán
Managing Director Spain. LOHMANN-BREEDERS Spain



Nutrición y Calidad del Huevo

10:00 - 10:15
10:15 - 10:30
El control del peso y el tamaño del huevo en ponedoras comerciales de acuerdo a las preferencias de mercado
Estrategias nutricionales para mejorar la calidad del huevo y la extensión del ciclo productivo de la gallina ponedora

Reza Akbari Moghaddam Kakhki
Poultry Nutrition Research
Scientist Poultry Research
Centre Trouw Nutrition

Joel Estevinho
European Poultry Technical Manager en Alltech
10:30 - 10:45
10:45 - 11:15
Calcio en acción: transformando el metabolismo óseo y fortaleciendo la cáscara del huevo
Diálogo entre expertos: Nutrición y calidad del huevo

Julio Díaz Berrocoso, PhD
Gerente Técnico I+D Avicultura de Tecnovit - FARM FAES



El control del peso y el tamaño del huevo en ponedoras comerciales de acuerdo a las preferencias de mercado BLOQUE 1 | Nutrición y Calidad del Huevo
control del peso y el tamaño del huevo en ponedoras comerciales de acuerdo a las
Reza Akbari Moghaddam Kakhki 10:00 - 10:15

Reza Akbari Moghaddam Kakhki
Poultry Nutrition Research Scientist Poultry
Research Centre Trouw Nutrition
Doctorado en Nutrición Animal.
Conocimiento profundo en nutrición animal.
Competente en análisis e interpretación de datos, y con habilidades en el diseño y realización de experimentos con animales.
Experto reconocido en la industria avícola, con un historial comprobado de proyectos exitosos.

Autor y coautor de más de 20 artículos revisados por pares, y con experiencia en la presentación de resultados de investigaciones en conferencias científicas y eventos de la industria.
En respuesta a los desafíos apremiantes que enfrenta la industria del huevo, el concepto de gallinas de larga vida surge como una solución prometedora y transformadora para hacer que sector de avicultura de puesta sea más sostenible (Bain et al., 2016).
Estas gallinas de larga vida presentan una alta tasa en la capacidad de puesta, que supera el ciclo convencional de la industria, ofreciendo un potencial significativo para mejorar la sostenibilidad.
Al alargar la vida productiva de las gallinas, los agricultores pueden reducir la necesidad de reemplazos frecuentes, lo que conlleva a una disminución de los sacrificios y la eliminación de aves.
Este enfoque más sostenible optimiza el uso de recursos como la tierra, el agua y el alimento, contribuyendo a un sistema de producción de huevos más eficiente (Bain et al., 2016)
A pesar de estos beneficios, la industria del huevo aún enfrenta desafíos persistentes relacionados con la seguridad alimentaria, el aumento de los costos de producción y las preocupaciones ambientales.
Uno de los problemas más críticos que afecta tanto a la eficiencia de producción como a la seguridad alimentaria es la disminución de la calidad de la cáscara, especialmente en las etapas finales del ciclo de puesta.
Los defectos en la cáscara, como las fisuras y roturas, pueden resultar en que hasta un 20% de los huevos sean degradados, lo que genera importantes pérdidas económicas para los productores (Benavides-Reyes et al., 2021)
Este problema se vuelve aún más relevante en las gallinas más viejas, ya que sus huevos tienden a ser más grandes, lo que aumenta las demandas sobre los procesos de mineralización de la cáscara.

El control del peso y el tamaño del huevo en ponedoras comerciales de acuerdo a las preferencias
La relación entre el peso del huevo y la calidad de la cáscara es especialmente destacable.
En los mercados donde los huevos se venden por peso, los huevos más grandes suelen tener un precio más alto.
Sin embargo, los huevos más grandes presentan mayores desafíos para mantener la calidad de la cáscara, ya que el área de superficie aumentada requiere más calcio y otros minerales para una mineralización adecuada.
Este desequilibrio entre el aumento de la superficie y la deposición mineral disponible puede llevar a cáscaras más delgadas y frágiles (Park y Sohn, 2018)
Como resultado, aunque los huevos grandes pueden ser más ventajosos económicamente en gallinas jóvenes; en gallinas de mayor edad, donde la mayoría de los huevos ya se encuentran en categorías de mayor precio, un tamaño excesivo no es deseable por sus consecuencias sobre la calidad de la cáscara.
En su lugar, surge una necesidad creciente de moderar el peso del huevo para mantener o mejorar la calidad de la cáscara a medida que las gallinas envejecen, especialmente en aquellas de larga vida.


En este contexto, los aminoácidos dietéticos juegan un papel clave en la optimización del rendimiento productivo y el mantenimiento de la calidad de la cáscara (Lemme, 2009; Macelline et al., 2021)
Gran parte de la investigación existente sobre la nutrición de aminoácidos en gallinas ponedoras se ha centrado en maximizar parámetros como la producción de huevos, la masa de huevo y la tasa de conversión alimenticia (Akbari Moghaddam Kakhki et al., 2016b; Lemme, 2009). Sin embargo, las etapas tardías de la vida productiva de la gallina presentan un desafío diferente, donde se vuelve esencial controlar el aumento de peso del huevo para preservar la calidad de la cáscara.
Esto abre la oportunidad de manipular los niveles de aminoácidos dietéticos para ralentizar el deterioro de la resistencia y el grosor de la cáscara, lo que ayuda a reducir la incidencia de huevos degradados sin sacrificar el rendimiento productivo.
Para explorar ésto, en los últimos meses hemos llevado a cabo dos estudios consecutivos en nuestro centro, The Poultry Reseach Centre, de Trouw Nutrition, en Toledo, donde hemos estudiado los efectos de las modificaciones de aminoácidos dietéticos sobre el rendimiento productivo y la calidad de la cáscara en gallinas ponedoras.
El control del peso y el tamaño del huevo en ponedoras comerciales de acuerdo a las preferencias de mercado
El primer estudio examinó los efectos de diferentes niveles de lisina digestible (dLYS) y distintos ratios con los aminoácidos azufrados digestibles (dTSAA) en gallinas ISA Brown desde las 62 a las 74 semanas de edad.

Un total de 288 gallinas fueron alojadas individualmente y asignadas a ocho tratamientos, combinando dos niveles de dLYS (5.9 y 5.5 g/kg con una ingesta de alimento de 120 g/ave/día) con cuatro ratios de dTSAA (90, 85, 80 y 75).
Los resultados mostraron que reducir el nivel de dLYS de 5.9 a 5.5 g/kg mejoró la resistencia y el grosor de la cáscara, aunque se observaron reducciones en el peso del huevo cuando la relación dTSAA cayó por debajo de 85.
Este experimento demostró que los ajustes en los aminoácidos dietéticos pueden ralentizar el deterioro de la calidad de la cáscara sin afectar negativamente la producción de huevos.
Sobre la base de estos hallazgos, se llevó a cabo un segundo estudio en gallinas Lohmann Brown desde las 82 a las 92 semanas de edad para investigar más a fondo los efectos de los niveles variables de dLYS.
Un total de 240 gallinas fueron alojadas individualmente y asignadas a seis tratamientos dietéticos, donde los niveles de dLYS se ajustaron en incrementos de 5.12 a 6.72 g/kg con una ingesta de alimento de 120 g/ave/día.
Los resultados mostraron que aumentar el dLYS de 5.12 a 5.76 g/kg mejoró significativamente la producción de huevos por día de gallina y la masa de huevo, mientras que mayores aumentos no generaron beneficios adicionales de producción.
La incidencia de huevos fárfara se minimizó en niveles intermedios de dLYS, pero la calidad de la cáscara se deterioró cuando los niveles de dLYS superaron los 6.08 g/kg.

Estos estudios destacan la importancia de ajustar los niveles de aminoácidos dietéticos como una estrategia potencial para mejorar la calidad de la cáscara, particularmente en gallinas
mayores durante las etapas tardías del ciclo de puesta.
Al equilibrar cuidadosamente los niveles de lisina digestible y mantener una relación adecuada con los aminoácidos azufrados digestibles, los productores pueden manejar los aumentos de peso del huevo mientras mitigan el deterioro de la resistencia y el grosor de la cáscara.
Este enfoque ofrece una solución práctica a uno de los principales desafíos de la industria del huevo, mejorando tanto la productividad como la sostenibilidad al reducir la degradación de los huevos y garantizar un suministro más consistente de huevos de alta calidad.
Aunque se necesita más investigación para perfeccionar estas estrategias, los hallazgos sugieren que la optimización de los perfiles de aminoácidos puede desempeñar un papel crucial en el mantenimiento del rendimiento a largo plazo de la puesta y en la mejora de la calidad de la cáscara en las operaciones comerciales. aviforum.info
El control del peso y el tamaño del huevo en ponedoras comerciales de acuerdo a las preferencias de mercado
[32 estudios realizados en 30 992 ponedoras]
Puesta
Alimento por kg de huevo
+2% -51g -39%
La inclusión de BIOPLEX® en dietas de ponedoras resultó en una reducción significativa de la huella de carbono, tanto en alimentos con alto GWP, como en alimentos con bajo GWP*.
2,5% reducción
-1040 680 1210
Por 1 m millón de ponedoras
Equivalente a automóviles en circulación por un año de la intensidad de emisiones por kg de huevo
Consumo eléctrico de
Vuelos intercontinentales de ida y vuelta 700
casas
* Global Warming Potential (Potencial de Calentamiento Global) Huevos rechazados

Joel Estevinho

Joel Estevinho
Responsable Técnico de Avicultura en Europa, Alltech
En Alltech desde 2020, como Responsable Técnico de Avicultura para Europa.
Formado en Medicina Veterinaria en 2005, por la universidad UTAD (Portugal).
Ha trabajado en varias empresas de avicultura en Europa y América del Sur, principalmente en los sectores de producción de huevo y de genética avícola.

A lo largo de su carrera ha ocupado diversos puestos técnicos y comerciales, en los cuáles dio soporte a empresas en más de 10 países.
Actualmente se enfoca en las áreas de producción de huevo en sistemas alternativos, sanidad y bienestar animal, calidad de cáscara, producción sostenible y reducción del uso de antibióticos, entre otras.
Las empresas de genética vienen logrando notables avances en la selección de ponedoras con mayor persistencia de puesta. El alargamiento del periodo potencial de puesta es acompañado por el progreso genético a nivel de la calidad de cáscara. En virtud de estas importantes mejoras, actualmente ya están disponibles estándares de producción hasta las 100 semanas de edad.
A pesar de esta evolución muy favorable en cuanto al potencial genético, en muchos países los lotes de ponedoras son reemplazados alrededor de las 80 semanas de edad, principalmente debido a factores no genéticos que afectan a la productividad y a la calidad de huevo.
Entre estos factores, toman especial importancia los defectos de la cáscara, que son el principal motivo para adelantar el reemplazo de un lote.
Los minerales traza son usualmente añadidos a los piensos en altos niveles, típicamente en la forma de minerales traza inorgánicos (MI).
A pesar de permitir alcanzar niveles aceptables de producción en la mayoría de las situaciones, la usual sobredosificación de MI está asociada a un menor aprovechamiento de los ingredientes de la dieta, debido principalmente al antagonismo entre los minerales traza y otros nutrientes.
A título de ejemplo, altos niveles de Calcio (Ca) y Fósforo (P) pueden reducir la utilización de Manganeso (Mn), a su vez el Mn compromete la utilización de Hierro (Fe), mientras el Zinc (Zn) tiene un efecto antagónico en el Cobre (Cu) y el Mn.
Además, debido a los altos niveles de minerales en los piensos para animales, se aumenta la posibilidad de formación de complejos entre los minerales traza y los macrominerales (Ca y P, principalmente) a nivel intestinal, afectando aún más a su biodisponibilidad.

Estrategias nutricionales para mejorar la calidad del huevo y la extensión del ciclo productivo de la gallina ponedora
Estas interacciones entre minerales están representadas, de manera resumida, en la Figura 1:

Figura 1: Interacciones entre minerales. Fuente: Miller (1979).
Otro inconveniente de los MI es su efecto oxidante, que perjudica la actividad y estabilidad de otros ingredientes.
Estas interacciones negativas fueron ya descritas, por ejemplo, para varias enzimas, vitaminas y antioxidantes sintéticos (Concarr et al., 2016)
El bajo pH del tracto digestivo superior reduce la digestibilidad de las sales de los MI, al causar su disociación y, por ende, dejándolos vulnerables a la acción antagónica de varios nutrientes, empeorando así los efectos antes descritos (Byrne and Murphy, 2022)
El tipo de ligando (molécula con la cual el mineral traza forma un complejo o quelato) y el proceso de fabricación tienen un efecto directo en la fuerza de unión entre el ligando y la sal inorgánica. Estas características varían ampliamente entre productos (Byrne et al., 2021)
La fuerza de unión afecta a la estabilidad de un mineral en el premix, la cual determina el grado de interacciones con otros ingredientes de la premezcla, y también durante el proceso digestivo.
Por otro lado, aunque sea generalmente aceptado que los minerales traza orgánicos (MO) tienen mejor comportamiento que los MI respecto a las interacciones con otros nutrientes a lo largo del tracto digestivo, estudios recientes han demostrado que los MO con baja fuerza de unión a su quelato pueden no mejorar los resultados con relación a lo que ocurre con los MI (Murphy, 2018; Vieira et al., 2020; Concarr et al., 2021).
Los minerales proteinados Bioplex® (proteinatos) están quelatados con péptidos. Estos minerales son fácilmente absorbidos y metabolizados, aspecto de fundamental importancia y que permite optimizar su utilización por los animales.
La amplia investigación llevada a cabo en años recientes permitió demostrar la superior estabilidad y eficacia de Bioplex® en comparación con varias fuentes inorgánicas y orgánicas de minerales.
Las ventajas reportadas en esos estudios incluyen un significativo aumento en la estabilidad y actividad de diversas vitaminas, antioxidantes y enzimas (fitasa, xilanasa y proteasa).

Estrategias nutricionales para mejorar la calidad del huevo y la extensión del ciclo productivo
Los efectos de Bioplex® en la alimentación de ponedoras han quedado evidentes en un reciente meta-análisis (Byrne et al., 2023)
En ese meta-análisis, que analizó sistemáticamente los resultados de más de treinta pruebas, se demostró claramente que la utilización de Bioplex® permitió mejorar el porcentaje de puesta promedio, el índice de conversión de pienso, el peso de huevo promedio y la resistencia de la cáscara, entre otros parámetros. Estos efectos están representados, de manera resumida, en la Figura 2:

Figura 2: Efecto de la utilización de Bioplex® en ponedoras. Fuente: Byrne et al. (2023).
Además, esta significativa mejoría en los principales parámetros de productividad, eficiencia alimentaria y calidad de huevo estuvo asociada a una reducción en la huella de carbono por kilo de huevo, cuantificada a través de un Análisis del Ciclo de Vida (ACV):


Figura 3: Efectos de la inclusión de Bioplex® en piensos de ponedoras – parámetros productivos y huella de carbono por kilogramo de huevo. Fuente: Byrne et al. (2023).
El Análisis del Ciclo de Vida (ACV) antes mencionado fue realizado según la metodología de Alltech E-CO2
La empresa Alltech E-CO2 es pionera en el uso de herramientas y evaluaciones ambientales. Alltech E-CO2 realizó ya más de 20.000 evaluaciones en granjas a nivel mundial, y ha desarrollado modelos de evaluación para cultivos y todas las principales especies de animales de granja.
mejorar
extensión

Las evaluaciones ambientales certificadas de Alltech E-CO2 brindan una gran cantidad de datos detallados sobre producción animal, salud, alimentación, uso de fertilizantes, balance de nitrógeno, agua, energía y uso de otros recursos.
Los datos recopilados se utilizan para ofrecer programas prácticos en la granja y en línea, así como informes de referencia, con consejos de consultoría claros y concisos para reducir la huella de carbono y la huella hídrica de las explotaciones agropecuarias.

Figura 4: Modelos de evaluación de la huella de carbono de Alltech E-CO2.
Todos los modelos Alltech E-CO2 están acreditados de forma independiente por Carbon Trust, ya que Alltech ha acreditado su gama de herramientas de evaluación a medida. Cada uno de los modelos desarrollados está certificado para cumplir con el estándar de huella de carbono del producto PAS 2050 (BSI, 2011).
Una huella de carbono es el indicador global de la eficiencia de las explotaciones agropecuarias.
Alltech E-CO2 calcula la huella de carbono utilizando las emisiones de gases de efecto invernadero (GEI) que son generadas en cada una de las etapas asociadas a la producción de huevo, a través de una metodología de ACV acreditada por Carbon Trust.
Estas emisiones, que pueden provenir tanto directamente de las aves, como indirectamente de la producción de piensos y demás insumos contabilizados en el sistema de la explotación, se compilan en una unidad patrón de evaluación, que es la cantidad de CO2 equivalente emitida por unidad funcional.
La docena de huevos y el kilogramo de huevo son las unidades funcionales más usadas en el ACV.

Figura 5: Ciclo de vida de un producto avícola (simplificado).
Algunos ingredientes generan una mayor huella de carbono que otros, por lo que el reemplazo de determinados ingredientes por alternativas más sostenibles puede aportar beneficios importantes.
La aplicación del modelo de evaluación Feeds EA™, cuya base de datos contiene ya más de 600 ingredientes, permite medir y reducir la huella de carbono asociada a los piensos.
La información generada por Feeds EA™ también puede ser incluida en el cálculo de la huella de carbono de una granja, o en cualquier otra evaluación que calcule la huella de carbono de una empresa.
Estrategias nutricionales para mejorar la calidad del huevo y la extensión del ciclo productivo de la gallina
¡Huevos más grandes, cáscaras más fuertes!
Calidad de huevo superior con PIDOVIT: mejora el peso, la calidad del albumen y la dureza de la cáscara, logrando una mayor resistencia y frescura en cada puesta.

MÁS CALCIO IÓNICO DISPONIBLE PARA LA ABSORCIÓN INTESTINAL


MÁS CALCIO TRANSFERIDO A LA SANGRE

MÁS CAPACIDAD ÓSEA DE DEPOSICIÓN Y MOVILIZACIÓN

PIDOVIT es una solución en polvo a base de fuentes altamente digestibles de calcio y vitamina D3, que maximiza el depósito mineral para la obtención de huesos y huevos más resistentes.
Calcio en acción: transformando el metabolismo óseo y fortaleciendo la cáscara del huevo BLOQUE 1 |

10:30 - 10:45 Miércoles 23 de octubre 2024
Julio Díaz Berrocoso, PhD

Julio Díaz Berrocoso, PhD
Gerente Técnico I+D Avicultura de Tecnovit - FARM FAES
Julio Díaz es un profesional con un destacado perfil académico y más de 15 años de experiencia en el sector agropecuario, especializado en la nutrición animal, particularmente en avicultura.
Posee un Doctorado en Nutrición Animal por la Universidad Politécnica de Madrid, donde se graduó Cum Laude.
Además, cuenta con un Máster en Agroingeniería y un Grado en Ingeniería Agronómica por la Universidad de Extremadura.
A lo largo de su carrera, Julio ha ocupado cargos clave en investigación y desarrollo en reconocidas empresas del sector agroalimentario. Actualmente es Responsable Técnico de Avicultura I+D en Farm Faes (Madrid), donde lidera la investigación y desarrollo en nutrición avícola.
Además de su experiencia en la industria, Julio ha trabajado como investigador académico en la Universidad de Hawái en Manoa, donde realizó estudios postdoctorales en nutrición temprana, fisiología intestinal y digestibilidad de aminoácidos en pollos.

Su sólida formación técnica, combinada con su experiencia práctica en investigación, formulación de piensos y gestión de proyectos, le permite contribuir de manera significativa a la mejora de la nutrición y el rendimiento animal.
El calcio es un macromineral esencial para diversos procesos fisiológicos en las aves, especialmente en animales con aptitud productiva como es el caso de las gallinas ponedoras.
Dentro del organismo, el 99% del calcio está presente en los huesos, en forma de hidroxiapatita (fosfatos de calcio) y el 1% restante en los espacios intracelular y extracelular.
El calcio extracelular representa tan sólo el 0,1% del calcio corporal total y está presente en tres formas: calcio ionizado, calcio unido a proteínas y calcio unido a aniones. El calcio ionizado es la única forma fisiológicamente activa de calcio en las aves.
En el caso de las gallinas ponedoras, estas desarrollan el hueso medular, que no es un tejido óseo per se, sino que se desarrolla dentro de las cavidades de la médula de los huesos largos.
Este hueso medular es metabólicamente activo y puede reabsorberse fácilmente para liberar calcio.
El hueso medular sirve como depósito de calcio para la calcificación de la cáscara de huevo durante la noche, cuando las gallinas no comen y el suministro de calcio intestinal se agota.
Dentro del huevo, la cáscara supone un 9% del peso del huevo y se compone de carbonato cálcico (94%), carbonato magnésico (1%), fosfato cálcico (1%) y materia orgánica (4%). La cáscara de huevo es un conjunto de capas o estructuras que tienen un papel fundamental en la defensa física contra impactos mecánicos así como evitar la contaminación por microorganismos (Hincke et al., 2012). Desde dentro hacia fuera, la cáscara de huevo está compuesta por (Figura 1):
Membranas testáceas (interna y externa), suponen aproximadamente un 3% del peso del huevo y son barreras defensivas del huevo contra la contaminación. La membrana interna rodea la clara de huevo y la membrana externa es más gruesa y está unida a los conos mamilares (parte interna de la capa mineral).
Las fibras de estas membranas están compuestas por aproximadamente un 10% de colágeno (tipos I, V y X) y un 70-75% de otras proteínas y glucoproteínas. Esta matriz orgánica desempeña un papel clave en la modulación de la formación de la cáscara, ya que en cada etapa está presente un perfil particular de proteínas específicas en el fluido uterino (Gautron et al., 1997)
Calcio en acción: transformando el metabolismo óseo y fortaleciendo

Capa mineral. Es la capa más gruesa de la cáscara y esta capa está formada por los conos mamilares, membrana mamilar y por la capa empalizada. Esta capa está formada por cristales columnares de calcita (carbonato cálcico).
Cutícula. Esta capa orgánica recubre la superficie externa de la cáscara y su función es tapar los poros de la cáscara (entre 7.000 y 15.000 poros) para evitar la entrada de bacterias y patógenos a través de la cáscara.
CAPA DE CRISTAL VERTICAL
PORO CUTÍCULA
CAPA MAMILLAR
MEMBRANA INTERNA DE LA CÁSCARA

CAPA EN EMPALIZADA
MEMBRANA EXTERNA DE LA CÁSCARA
El proceso de mineralización del huevo en gallinas ponedoras requiere una gran cantidad de calcio.
El calcio que se deposita en la cáscara llega por circulación sanguínea, conteniendo alrededor de 2,5 g de calcio en aves de alta producción, equivalente al 8-10% del peso total de calcio presente en el organismo.
Es importante resaltar que estos 2,5 g son constantes durante toda la vida productiva de la gallina independientemente de la edad de la gallina o el tamaño del huevo.
La deposición de la cáscara de huevo ocurre en tres etapas
La primera etapa dura aproximadamente 5 horas y corresponde al inicio de la mineralización.
a. Los primeros cristales de calcita se nuclean en los sitios de los agregados orgánicos presentes en la superficie de las membranas de la capa externa.
b. Durante la primera etapa de mineralización, el crecimiento de cristales es calcita radial.
c. Los sitios de nucleación se convierten en el origen de los conos mamilares.
d. A medida que estos crecen hacia afuera, se unen gradualmente para formar las bases de la capa de empalizadas.
acción:

La segunda etapa es el crecimiento rápido de la calcita policristalina para formar la capa de empalizada.
a. La formación de las empalizadas ocurre en el espacio libre disponible, produciendo cristales que crecen perpendicularmente a la superficie de la cáscara en formación.
b. En este caso, el crecimiento de los cristales desde el sitio de nucleación ocurre inicialmente en todas las direcciones, pero, debido a la competencia por el espacio entre sitios de crecimiento adyacentes, solo los cristales que crecen perpendicularmente a la superficie del huevo tienen espacio para crecer.
La última etapa corresponde a la terminación de la calcificación y dura aproximadamente 1,5 horas.
a. La detención de la mineralización ocurre en un líquido uterino que permanece sobresaturado en iones de calcio y bicarbonato.

Como hemos podido ver en los apartados anteriores, el papel del calcio es fundamental y necesario para la formación de la cáscara. Sin embargo, todas las fuentes de calcio no son iguales y van a variar en una serie de factores que a nivel nutricional podemos controlar, pudiendo manipular la calidad de la cáscara. Dentro de estos factores tenemos:
Composición química
Solubilidad in vitro
Biodisponibilidad
Granulometría
La solubilidad es un factor principal que va a depender del pH del tracto gastrointestinal y la velocidad de disolución está influida por el tamaño de las partículas.
Otro aspecto fundamental es la granulometría o tamaño de partícula y su fuente, ocasionando diferencias en su liberación y absorción durante el proceso de formación de la cáscara. En general, la utilización de fuentes de calcio grueso presenta solubilidad más lenta, pero tienen tiempos de retención más largos en la molleja.
A medida que se disuelve más lentamente, el aporte de calcio al organismo se hace de una manera más equilibrada, en conjunto con el mantenimiento de la concentración en sangre durante la noche, momento en el que ocurre la formación
de la cáscara.

Llegado a este punto, se podría pensar que para mejorar la mineralización del huevo y por consiguiente de la cáscara del huevo, bastaría con aumentar los niveles de calcio en la dieta.
Sin embargo, utilizar niveles de calcio por encima de los requerimientos recomendados no mejora significativamente la calidad de la cáscara (Keshavarz, 2002).
Por otro lado, si no se administra una cantidad adecuada de calcio a una edad temprana, puede resultar en una alta probabilidad de tener problemas con el metabolismo del calcio y las reservas óseas de calcio (Roland y Bryant, 2000)
Por lo tanto, más allá de los niveles de calcio, la utilización de fuentes de calcio altamente digestible puede utilizarse en sinergia con otras estrategias para mejorar la calidad de la cáscara del huevo.
En este sentido, fuentes orgánicas de calcio que no sean pH-dependientes, como el pidolato de calcio, pueden garantizan una mejor absorción intestinal, una fácil circulación en la sangre y una excelente unión a los tejidos.


Además de fuentes de calcio altamente disponibles, el suministro de calcio al útero y la calidad de la cáscara pueden ser incrementados por los metabolitos de la vitamina D que estimulan algunos transportadores de calcio en el útero para el 25(OH)D3 y en el intestino para el 1,25(OH)2D3. El suministro de metabolitos activos de la vitamina D de origen químico o vegetal aumenta el suministro de calcio para la cáscara del huevo, al mejorar su absorción intestinal.

aviforum.info
Calcio en acción: transformando el metabolismo óseo y fortaleciendo






Ibérica de Tecnología Avícola, S.A.U
Calle Tomás Cerdá, 7 - Parque Tecnológico de Boecillo (Valladolid) 47151
Tlf: (+34) 983 548 163 www.ibertec.es
Bloque 2
Nutrición y sostenibilidad avicultura puesta

11:15 - 11:30
11:30 - 11:45
La huella de carbono y la alimentación y nutrición de ponedoras
Importancia de la conformación corporal de las gallinas para optimizar los parámetros productivos en puesta

Jon de los Mozos
Technical Manager Poultry en Nutreco Iberia

Diego García
Poultry Technology Application Specialist Cargill
11:45 -12:00
Diálogo entre expertos: Nutrición y calidad del huevo

12:00 - 12:45
COFFEE BREAK



Jon de los Mozos
Technical Manager Poultry en Nutreco Iberia
Estudió Ingeniería Agronómica en la Universidad Politécnica de Madrid, donde se especializó en nutrición y producción animal.
Empezó a trabajar en junio de 2003, en el centro de investigación avícola que Nutreco tiene en Casarrubios del Monte (Toledo), como investigador. Allí gestionó distintos proyectos de nutrición tanto en pollos, gallinas como reproductoras pesadas.

Su inquietud por saber más del negocio le lleva a trabajar en Trouw Nutrition España como Jefe de Producto de Avicultura, tratando de ayudar a los clientes y productores avícolas a rentabilizar sus negocios con los recursos de Trouw. Y, desde enero de 2024 es director técnico de avicultura de Nutreco Iberia.
Ha participado en distintos congresos científicos y colaborado en revistas especializadas, siempre tratando el tema de la nutrición avícola y sus derivadas.
La mejora en la eficiencia de la alimentación, aumento de la productividad, longevidad y mejora de la salud de los animales, entre otros, han sido hasta ahora impulsores de la sostenibilidad ambiental del sector sin que esto haya sido parte de un plan de reducción de emisiones.
De hecho, las estimaciones de la evolución de la huella ambiental en los últimos años así lo reflejan.
En el sector ganadero, las aves son la especie que menos emisiones de gas invernadero genera por kilogramo de proteína producida (Gráfico 1).
Emisiones de CO2-eq por kg de proteina
kg de CO2eq por kg de proteina
Gráfico 1: Emisiones de CO2-eq por kilogramo de proteína. Fuente: http://foodandagricultureorganization.shinyapps.io/GLEAMV3_Public
Desde luego, es para hacer gala de la eficiencia del sector, además de servir de motivación a seguir contribuyendo con los compromisos medioambientales en todas las partes de la cadena de valor para mantener el liderazgo y servir de ejemplo.
Para dar la información del cálculo y monitorización del impacto ambiental de las explotaciones, en primer lugar, es necesario conocer a través de la metodología del análisis de ciclo de vida (ACV), la huella ambiental (HA) de los piensos.
Esta se calcula a través de la metodología PEFCR (Product Environmental Foodprint Category Rules), las Reglas de categoría de la huella medioambiental de los productos (FEFAC 2018 en el caso de los piensos).
Consiste en combinar la información de HA de las materias primas (Gráfico 2) (mediante bases de datos secundarias, GFLI, Agri-footprint, Agribalyse, Econinvent) y los propios datos de la empresa (energía empleada en el proceso de fabricación, transporte del pienso a destino).

En segundo lugar, debemos poder cuantificar las emisiones que se generan en la propia explotación mediante una metodología basada en estándares internacionales (IPCC 2021, guía LEAP-FAO2016), para poder llegar a conocer la HA del producto final (Kg de carne, kg de huevos).
Las MTDs, planteadas por los reguladores, son un refuerzo a este compromiso de la ganadería para seguir reduciendo el impacto medio ambiental de nuestras granjas.
Está claro que la presión social y legislativa hacen que tengamos que demostrar la implicación del sector primario, como no, incluyendo el de la avicultura de puesta, en su compromiso por mejorar la sostenibilidad ambiental de esta producción.
Podemos tener en cuenta que como se ha dicho anteriormente, la implantación de medidas técnicas disponibles en la alimentación, como es la alimentación en fases, ya supone una importante reducción de huella ambiental (Tabla 1).
La huella de carbono y la alimentación y
Tabla 1: Cambio climático (kg de CO2-eq. por kg de huevo producido) en los dos escenarios. Fuente, software de ACV de gallinas ponedores (myfeedprint).
El uso de enzimas, que permiten una mejor utilización de la energía de los cereales o las proteínas de los subproductos proteicos o el fósforo fítico de la dieta, también permiten reducir el uso de recursos sin impactar negativamente en la producción de las gallinas, lo que se traduce en una reducción de la huella ambiental.
La utilización de aditivos que puedan mejorar la salud de los animales, reduciendo la prescripción veterinaria de antibióticos, y limitando el impacto de patologías subclínicas que tienen un efecto negativo en la producción y mortalidad de los lotes de gallinas, también participan en la mejora de la huella ambienta.
Otra parte importante implicada en las emisiones es la elección de materias primas.
El origen de ellas, así como el uso del suelo en su cultivo y producción, tienen impacto en la evaluación de la huella de carbono por kg de huevo.
Cabe destacar que en este apartado es importante trabajar en la trazabilidad y origen de las materias primas, así como en una mayor armonización y transparencia de las prácticas que nos lleven a cuantificar de forma correcta su impacto.



Gráfico 2: Kg de CO2-eq. Por kg de cultivo por origen.
Conclusiones
Es importante recalcar que el sector avícola y en especial el avícola de puesta es uno de los sectores de producción animal que menos impacto tiene por kg de proteína producida.
Sin embargo, esto no quita que se deban seguir implementando medidas, también a través de la nutrición que hagan mejorar la huella ambienta de esta producción.






Diego García*
*Diego García Valencia, Lieske Van Eck, Ines Carvalhido y Raúl Benito Cargill Premix and Nutrition

Diego García
Poultry Technology Application Specialist Cargill
Diego García Valencia es un experto en nutrición animal con más de 20 años de experiencia, centrado principalmente en la industria avícola.
Posee un Doctorado en Nutrición Animal por la Universidad Politécnica de Madrid (2008), donde investigó sobre nutrición y producción en avicultura y porcicultura.
Además, cuenta con títulos en Ingeniería Agronómica por el Ministerio de Educación de España (2001) y Ciencias Animales por la Universidad Nacional de Colombia (1998).
A lo largo de su carrera, Diego ha ocupado cargos relevantes en empresas multinacionales del sector agropecuario.

Ha publicado en prestigiosas revistas científicas, como Animal Feed Science and Technology, British Journal of Nutrition, Journal of Animal Science y Poultry Science, sumando más de 20 artículos revisados por pares. También ha contribuido a más de 40 congresos científicos internacionales y ha sido ponente invitado en importantes eventos.
El potencial genético de las ponedoras ha mejorado la persistencia de la puesta de manera sustancial en los últimos años. Dicha mejora conlleva el desarrollo de una nutrición adecuada a las exigencias de las genéticas actuales con tal masa de huevo y persistencia de puesta.
En este sentido, es crucial alimentar a la pollita correctamente, incidiendo principalmente en la alimentación al inicio de la puesta cuando el animal está aún creciendo y llegando al pico de puesta.
En la recría se necesita hacer una pollita robusta para que se pueda mantener una alta producción de huevos a largo plazo.
Por ello, centrarse en el desarrollo adecuado de la pollita durante la recría es clave y uno de los puntos más importantes es prevenir el exceso o deficiencia de peso.
Como se puede observar en el Gráfico 1, la producción temprana de huevos es mayor cuando las pollitas tienen una cantidad inicial de grasa corporal más baja (Milistis et al., 2015).

Gráfico 1: Efecto de la cantidad de grasas corporal sobre la producción de huevos (Milistis et al., 2015).
En este sentido, alimentar a las pollitas para que desarrollen los órganos en el momento idóneo es fundamental.
Para ello, al formular los piensos se debe tener en cuenta que durante las dos primeras semanas de vida el aumento de peso se debe principalmente al crecimiento de la pechuga y del tracto gastrointestinal.
Si embargo, entre la tercera y octava semana (a pesar de que la pollita continúa con un crecimiento rápido debido al crecimiento muscular, de los órganos no reproductivos y del esqueleto) se puede reducir ligeramente la densidad de la dieta.
A continuación, entre la octava y la decimosegunda semana, el crecimiento es más estable, se alcanza el pico de desarrollo muscular y óseo y se puede reducir aún más la densidad del alimento.
Finalmente, entre la decimotercera y decimosexta semana el crecimiento es reducido y se inicia el desarrollo del oviducto y la deposición de grasa abdominal. En este periodo hay riesgo de deterioro de órganos si el animal no recibe la cantidad de nutrientes necesarios.
A partir de la decimoséptima semana y hasta que se alcanza el 5 % de puesta, la gallina tiene el pico de crecimiento debido al desarrollo del oviducto y de la grasa abdominal. En este momento se hace necesario aumentar la densidad de la dieta y comenzar a introducir carbonato grosero.
En el Gráfico 2, se muestra la diferencia de la curva de crecimiento en estirpes blancas y marrones actuales y la evolución que han tenido (Van Eck et al., 2023) al ser comparadas con estirpes blancas de los años noventa (Kwakkel et a., 1992).

Se puede observar que hay un retraso en el pico de crecimiento de dos semanas en las estirpes modernas (20 Vs. 18 semanas, respectivamente) y que el pico es de casi el doble que en las estirpes de los años 90.

Gráfico 2: Comparación de la curva de crecimiento de estirpes blancas y marrones modernas con estirpes blancas de los años 90 (Van Eck et al., 2023).
En la fase de producción, para maximizar la producción de huevos a largo plazo, es necesario estimular la ingestión de alimento para asegurar una ingesta adecuada de nutrientes desde el inicio de la puesta porque la gallina está creciendo aún, alcanzando el pico de puesta y está acostumbrándose a un pienso poco palatable con un nivel de minerales muy alto. Esta situación, lleva al animal a un balance energético negativo que agrava la situación de estrés que vive el animal, convirtiéndose esta fase en un reto a nivel de manejo y nutrición.
La energía consumida a diario influye de manera importante en la forma de la curva de producción y si la gallina no es capaz de consumir la cantidad de alimento diario suficiente para cubrir las necesidades diarias, debe ajustarse la energía del alimento para que, con el consumo diario actual, el nivel de energía consumida sea el necesario.
Tampoco es adecuado suministrar un exceso de energía a las gallinas y llevarlas a sobrepeso, ya que esto va en contravía del bienestar de las gallinas y del correcto funcionamiento del hígado dado que, si se abusa del uso de almidón a costa de la grasa añadida en los piensos, mayor será la incidencia de hígado graso.
Los requerimientos nutricionales cambian con el tiempo debido a una reducción en la tasa de puesta, un aumento en el peso del huevo y un aumento en las necesidades de mantenimiento debido a pesos corporales más altos, con una diferencia también en la composición corporal de dichos animales.
Estos cambios requieren un cambio en las estrategias de alimentación con el tiempo para apoyar la producción de huevos a largo plazo (Van Eck et al., 2024).
Milistis et al., 2015, no observaron diferencias en el porcentaje de puesta a 72 semanas de vida entre las gallinas que iniciaron la puesta con más de 40 g de grasa abdominal y las gallinas que iniciaron la puesta con menos de 20 g.
Sin embargo, en el periodo productivo total, las gallinas con más grasa corporal al inicio de la puesta pusieron un 5% menos que las gallinas con menos grasa corporal al inicio de la puesta (Gráfico 1).
Reducir la energía del pienso es beneficioso para la producción de huevos a largo plazo ya que promueve el aumento del consumo de alimento.
El peso bajo de la almohadilla de grasa abdominal al inicio de la puesta se correlaciona con una mayor producción de huevos.
Por tanto, parece que una deposición de grasa corporal baja hasta aproximadamente las 40 semanas de vida es deseable para una mejor producción de huevos a largo plazo.
Sin embargo, dicha grasa corporal debería aumentar después de la semana 40 para mantener un nivel productivo adecuado.
Un mayor peso corporal de las gallinas al inicio de la puesta podría ser beneficioso para obtener una mayor producción y peso del huevo.
De hecho, al separar las gallinas pesadas de las ligeras en un mismo lote al inicio de la producción (1820 semanas de edad), y al alimentarlas con el mismo pienso se obtuvo una mayor producción y un mejor peso del huevo en las gallinas pesadas en comparación con las gallinas ligeras (Pérez-Bonilla et al., 2012)
Además, las pollitas con mayores pesos corporales al inicio de la producción inician la puesta antes y tienen pesos de huevo más altos a largo plazo (Summers y Leeson, 1994).
Importancia de la conformación corporal de las gallinas para optimizar

Sistemas probados libres de jaulas Chore-Time

Sistema de nidos

Sistema de recría
¿En qué se diferencian los aviarios de varios niveles de otros sistemas? Lea el informe técnico en choretime.com/Multi-Tier

Sistema de aviarios

Bloque 3
Bioseguridad en avicultura de puesta

12:45 - 13:00
13:00 - 13:15
13:15 - 13:30
13:30 - 14:00
Bases prácticas para la bioseguridad en granjas avícolas de postura
La nueva era en la desinfección del agua en granjas de puesta Ácido hipocloroso: desinfectante inocuo e higienizante con efecto bioestimulante que mejora la productividad de las aves
Diálogo entre expertos: Bioseguridad en granjas avícolas

David García Páez Consultor internacional en Bioseguridad

Grégoire Gaume
Director Técnico Aquactiva Solutions SL

José Antonio Martínez
Ingeniero de desarrollo e investigación en ORPNovatio y BIODYNA SL

ALMUERZO DE TRABAJO 14:00 - 16:00

David García Páez

David García Páez
Consultor internacional en Bioseguridad, OneSilex
Con una sólida formación académica que incluye una licenciatura en Farmacia, Máster Internacional en Toxicología, Máster en Control y Gestión de Plagas, y un Máster en Marketing y Comunicación, demuestra su compromiso con la excelencia y la innovación en su campo.
Ha ocupado el cargo de director técnico en una destacada empresa fabricante de biocidas, donde ha desarrollado su actividad en España, Latinoamérica y el Sudeste Asiático.

Su experiencia y conocimientos le han permitido contribuir con varias publicaciones en revistas especializadas de producción animal y participar como ponente en congresos nacionales e internacionales en el ámbito de la bioseguridad.
Además, David asesora a importantes empresas en el sector pecuario, en el área de la industria alimentaria y la defensa vegetal, confeccionando protocolos de bioseguridad e implementando auditorías de calidad en estos sectores.
La bioseguridad es un concepto fundamental en la prevención de enfermedades infecciosas, que abarca una serie de medidas para evitar la entrada, diseminación y el acantonamiento de enfermedades en las explotaciones de producción animal.
Podríamos hablar de bioseguridad pasiva que es dependiente de factores geográficos y ambientales (clima, densidad de granjas en la zona, zonas de paso para aves migratorias, etc.)
Mientras que la bioseguridad activa se centra en prácticas internas de la granja, y que las vamos a agrupar en 4 grandes áreas generales:
Personal, Vectores, Alimento y Manejo.
Este artículo explora, de forma básica y resumida, las estrategias y prácticas esenciales para mantener altos estándares de bioseguridad en las granjas de postura comercial. Veámoslos:
Trabajadores de la explotación
Uno de los principales desafíos en las explotaciones avícolas es la dificultad para encontrar trabajadores dispuestos a dedicar su tiempo y esfuerzo al manejo diario de estas instalaciones.
Una vez que se logra contar con personal comprometido, es fundamental invertir en su formación, independientemente de sus capacidades previas.
La capacitación adecuada no solo debe enfocarse en la puntualización de las tareas diarias, sino también en el correcto cumplimiento de las hojas de registro, lo que es esencial para la supervisión de los veterinarios de explotación, cuyo tiempo es limitado por la necesidad de realizar visitas a múltiples granjas.
El personal es, sin duda, uno de los aspectos más críticos a controlar para evitar la diseminación de microorganismos.
Además, es vital prevenir que los trabajadores se conviertan en reservorios de agentes patógenos, lo que podría poner en riesgo su salud y la de las aves.
Por lo tanto, el seguimiento riguroso del personal es esencial para garantizar la salud de las aves en un entorno seguro y saludable también.
Cabe considerar que enfermedades como la coriza aviar pueden introducirse en las explotaciones avícolas a través de los trabajadores que vacían las naves o que las llenan de pollitas.
Para mitigar este riesgo, la implementación de duchas y vestuarios equipados con ropa exclusiva para la explotación es primordial. Estas instalaciones no solo ayudan a prevenir la entrada de patógenos en el entorno, sino que también promueven una cultura de bioseguridad entre el personal.
Al establecer protocolos de higiene estrictos, se reduce significativamente la posibilidad de que microorganismos dañinos se diseminen, protegiendo la integridad de la explotación.


La subcontratación de personal externo o de empresas, es una práctica común, especialmente ante la escasez de mano de obra para ciertos trabajos, siendo cada vez más acuciante en nuestro sector.
Sin embargo, el verdadero desafío radica en el hecho de que estos equipos rotan entre diferentes granjas para realizar las mismas labores, lo que representa un riesgo significativo para la bioseguridad de la explotación.
Por esta razón, es crucial implementar un control riguroso sobre la bioseguridad de estos equipos, así como monitorizar las rutas de trabajo que realizan semanalmente.
Estas medidas nos permitirán minimizar los riesgos asociados a la subcontratación y proteger la salud de las aves y de la explotación.
Las visitas técnicas o comerciales son una oportunidad valiosa para fortalecer las relaciones con los clientes y proporcionarles una atención adecuada.
Durante estas visitas, es esencial llevar a cabo una evaluación exhaustiva de las instalaciones y los procesos operativos de la explotación.
Esto permite identificar áreas de mejora y ofrecer recomendaciones personalizadas que se alineen con las necesidades específicas de la explotación.
No obstante, es crucial realizar estas visitas con un enfoque riguroso desde el punto de vista de la bioseguridad. 3 4










Si no se toman las precauciones adecuadas, podríamos inadvertidamente introducir patógenos o contaminantes en la explotación, comprometiendo la salud de las aves y la integridad del negocio.
Por lo tanto, es fundamental que el personal que realice estas visitas esté capacitado en prácticas de bioseguridad y siga protocolos estrictos.
Antes de entrar en la explotación, es recomendable pasar por pediluvios secos así como vestir equipos de protección personal (EPP) adecuados. Asimismo,, se deben evitar el contacto con otras aves o instalaciones que no sean parte del sistema del cliente.
Solo así podremos garantizar que nuestras visitas no solo sean productivas, sino también seguras, protegiendo tanto al cliente como a su operación.
Registros y automatización de los procesos
El registro de las actividades del personal, la capacitación en relación con sus responsabilidades y las charlas informativas sobre los aspectos clave de la explotación son fundamentales para asegurar un desempeño eficiente en sus labores. Estas acciones son esenciales para fomentar un entendimiento profundo de los procedimientos y objetivos de la granja.
Además, la automatización de todos los procesos que dependen de la intervención humana es de vital importancia.
Esto no solo optimiza el funcionamiento, sino que también minimiza errores y mejora la consistencia en las operaciones diarias. 5
La falta de rotación de personal y las dificultades inherentes a ciertos trabajos subrayan la necesidad de implementar sistemas automatizados.

Hay 4 principalmente, y todos son igual de relevantes e importantes. Estos son:
Aves silvestres
Las aves silvestres son transmisoras y reservorios del virus de la influenza aviar, lo que hace imprescindible contar con un plan de prevención que no solo evite la propagación dentro de la explotación, sino que también establezca un plan de acción bien definido en caso de un brote.
Este plan debe asegurar la coordinación efectiva entre la integradora, la administración y la empresa de bioseguridad encargada de actuar en situaciones de emergencia, para evitar la inacción o falta de coordinación entre autoridades, integradora, granjero, etc.
El uso de mallas pajareras y otros elementos disuasorios es crucial para prevenir el anidamiento o la presencia temporal de aves silvestres en las instalaciones.
Además, es esencial controlar el crecimiento de malas hierbas, evitar la acumulación de agua de escorrentías entre las naves, y eliminar insectos y/o restos de pienso derramado que puedan atraer a estas aves dentro de la explotación.
Estos controles minimizan el riesgo de exposición al virus y contribuyen a la implementación de un plan de bioseguridad efectivo.
Ácaro Rojo (Dermanyssus gallinae)
Su control sabemos que es esencial en explotaciones avícolas, ya que afecta a la salud de las aves, provocando estrés, anemia y reducción en la producción de huevos. Además, es un vector de enfermedades, lo que aumenta su impacto negativo.
Para combatir este ectoparásito, se debe aplicar un enfoque integral que combine prevención, tratamientos químicos, y un monitoreo constante y continuo.
Un buen diseño del vacío sanitario y posterior seguimiento hasta 3-4 meses de la entrada de las pollitas es fundamental, especialmente en áreas donde el ácaro se esconde, como uniones, cintas, huecos y otros lugares reservorios.
Es importante rotar los acaricidas empleados para evitar resistencias, así como considerar el uso de control físico mediante productos minerales y orgánicos, así como en poco tiempo el control biológico con predadores naturales.
El monitoreo regular, mediante trampas y revisiones visuales, permite la detección temprana de infestaciones dentro de umbrales que sea aceptables para la integradora.
Un enfoque preventivo y correctivo minimiza el impacto del ácaro rojo en las aves y asegura la bioseguridad de la explotación.


Roedores: Rattus rattus (Rata de los tejados o negra), Rattus norvegicus (Rata de alcantarilla) y Mus musculus (Ratón común)
Los roedores, como ratas y ratones, representan un serio riesgo en las explotaciones avícolas, ya que no solo consumen alimento, sino que contaminan las instalaciones con sus heces y orina, actuando como vectores y reservorios de enfermedades y patógenos que pueden afectar tanto a las aves como a los humanos. Además, su capacidad para morder cables y equipos eléctricos puede ocasionar daños graves, como incendios y costosos desperfectos en equipos automatizados, incluidos los robots de las salas de clasificación.
Para un control eficaz, es fundamental implementar tanto medidas preventivas como correctivas.
El sellado de agujeros y grietas, así como la limpieza exhaustiva del alimento derramado, tanto en el interior de las instalaciones como en los silos exteriores, son pasos clave para evitar el acceso y anidamiento de roedores.
También es crucial eliminar posibles refugios, como áreas de maleza, escombros y puntos débiles en techos o paredes, donde los roedores suelen desplazarse.
El uso de cebos rodenticidas, trampas de captura y un monitoreo constante, junto con la rotación de métodos de control, son esenciales para prevenir infestaciones.Conocer su conducta permite aplicar técnicas efectivas, pero siempre siguiendo normativas para minimizar riesgos.
Un enfoque integral, iniciado durante el vacío sanitario y realizado por empresas especializadas en bioseguridad, es fundamental para mantener el control a largo plazo y garantizar la seguridad de las instalaciones.











No sólo porque actúan como vectores de patógenos que causan enfermedades como la salmonelosis, colibacilosis, incluso de endoparásitos como helmintos, sino también porque su presencia genera estrés en las aves así como malas condiciones de trabajo para el personal de la granja. Además, pueden contaminar los alimentos y las superficies de trabajo, afectando la calidad de los huevos.
Para su control, es necesario combinar medidas preventivas y activas.
La limpieza rigurosa y frecuente de las instalaciones, eliminando materia orgánica en exceso unido al control de la humedad en las fosas y alrededor de los bebederos limita las condiciones favorables para su proliferación.
El uso de insecticidas, tanto adulticida como larvicida, es de gran ayuda para evitar el desarrollo de resistencias.
Las trampas y cebos insecticidas colocados estratégicamente son herramientas útiles para reducir también la población de moscas.
El monitoreo constante de las poblaciones y la implementación de un enfoque integral son clave para mantener un entorno limpio y seguro para las aves, garantizando la eficacia del control de moscas a largo plazo.

Alimento seco
Es fundamental realizar una correcta limpieza y desinfección (L+D) de los silos y de las líneas de alimento o cadenas en seco, con el fin de evitar la acumulación de microorganismos entre lotes.
Esto es especialmente relevante para prevenir la contaminación provocada por la acumulación de agua tras el lavado de las naves en estos precisos lugares.
El proceso de limpieza debe realizarse en seco para evitar la presencia de humedad residual que pueda entrar en contacto con el pienso concentrado.
Asimismo, es crucial controlar los camiones que transportan el alimento, verificando sus rutas y asegurando que entreguen el tipo de pienso requerido sin errores, lo que evitaría entradas y salidas innecesarias de los vehículos.
Es importante vaciar por completo el sinfín del camión.
Además, el personal de transporte debe seguir estrictas medidas de bioseguridad, como el uso de ropa apropiada, para prevenir la introducción de contaminantes en las instalaciones así como el empleo de antisépticos para las manos y desinfectantes adecuados para la cabina.

La purga (flushing) de las líneas de agua de bebida es un proceso fundamental para eliminar residuos de biofilm, mucosidad, algas pardas, restos de medicamentos y/o suplementos alimenticios que puedan permanecer en las tuberías.
Esta práctica es esencial para evitar que las aves ingieran estas sustancias, las cuales podrían comprometer su salud.
Asimismo, la correcta potabilización del agua mediante productos que han demostrado ser eficaces es crucial.
Este proceso debe ir acompañado de una monitorización adecuada de parámetros como la temperatura, el pH, las ppm del biocida utilizado y el Potencial de Óxido Reducción (ORP), lo cual garantiza una desinfección eficiente del agua.
El diseño del sistema de potabilización debe basarse en un análisis exhaustivo de la fuente de agua utilizada en la explotación (ya sea pozo, tanque, afluentes, canales, etc.), en el que se incluyan tanto parámetros microbiológicos como fisicoquímicos.
Este análisis es clave para la posterior implementación del sistema de tratamiento.
Además, la acidificación del agua ya sea mediante ácidos orgánicos o inorgánicos, debe realizarse de forma correcta, con la dosis adecuada y durante el tiempo necesario, garantizando un control preciso para evitar problemas de ingesta en las aves.

La desinfección y desinsectación de los camiones de transporte, y vehículos que accedan a las instalaciones mediante arcos de desinfección que cubren toda su superficie exterior, incluidas las huellas de los neumáticos, es de vital importancia, ya que es en estas zonas donde tiende a acumularse gran cantidad de materia orgánica.
Implementar un sistema automatizado para la aplicación de biocidas, que no dependa del personal, es fundamental para garantizar el cumplimiento riguroso y la trazabilidad de los protocolos de bioseguridad.
Este tipo de sistemas automatizados, cuando se mantienen adecuadamente y son gestionados por personal profesional, aseguran una dosificación exacta y precisa de los biocidas.
Esto resulta clave para limitar la carga microbiana y controlar los vectores que podrían acceder a la explotación.
Además, contribuyen a una mayor eficiencia y consistencia en la protección de la granja de producción.

Desinsectación, Limpieza y Desinfección
El diseño e implementación de un plan de desinsectación, limpieza y desinfección (D+L+D) durante el vacío sanitario es fundamental para el buen desempeño en las explotaciones avícolas.
Es crucial la coordinación entre la empresa de bioservicios, el personal encargado de la limpieza y la ejecución de tareas en tiempos específicos, evitando solapamientos, para asegurar la efectividad de los biocidas utilizados así como los tiempos de contacto de los productos empleados.
Esta colaboración y profesionalidad garantizan la seguridad y eficacia dentro de la explotación. 2
Un vacío sanitario bien diseñado requiere la colaboración del personal de la granja, la empresa de limpieza y la empresa de bioseguridad, que debe certificar la aplicación adecuada de insecticidas y desinfectantes en cada etapa.
Además, es esencial que el manejo de estos productos sea realizado por profesionales especializados y cualificados, lo que debe estar documentado en el correspondiente certificado de bioservicio.

L+D de la sala de clasificación de huevos y “anacondas”
La entrada de partículas, materia orgánica, restos de plumón o cualquier elemento que pueda contaminar esa área debe revisarse cuidadosamente para mejorar el ambiente evitando la proliferación en este de fómites que pueden ser portadoras de carga microbiana.
Es fundamental eliminar diariamente el plumón, la materia orgánica y los restos de huevos rotos, llevando a cabo un riguroso proceso de limpieza seguido de desinfección. Esto no solo ayuda a controlar microorganismos, sino que también previene la diseminación de patógenos por el personal que trabaja en estas áreas.
Además, es crucial realizar la revisión e inspección de los desagües, donde pueden encontrarse larvas de moscas y restos de roedores, así como en zonas cercanas a los motores de los robots que operan en la sala.

La implementación de planes de higiene con registros detallados y el uso de técnicas como la bioluminiscencia permiten verificar el nivel de higiene y minimizar el riesgo de contaminaciones cruzadas antes de que los huevos lleguen a los lineales de los supermercados.
Una buena desinfección terminal por vía aérea mediante desinfección seca con productos autorizados para tal fin contribuye a garantizar la seguridad alimentaria y la calidad de los huevos.

La presencia de puertas que no cierran adecuadamente, agujeros sin sellar, sistemas de enfriamiento por evaporación (pad coolings) con calcificaciones, y la falta de higiene en áreas como cabeceras, traseras y pasillos son aspectos críticos que deben ser considerados por los veterinarios durante sus visitas a las explotaciones. Además, la inadecuada práctica en la recogida de cadáveres por parte del personal puede contribuir a problemas de bioseguridad y de salud animal.
Para abordar estas cuestiones, es fundamental establecer reuniones periódicas con el personal de cada nave, donde se definan claramente las funciones de cada miembro del equipo.
La formación continua y sistemática del personal no solo contribuirá a mejorar la higiene y el manejo de la granja, sino que también optimizará el funcionamiento interno de la organización.
Estas medidas proactivas son esenciales para garantizar el bienestar animal y la salud general de las explotaciones avícolas.



Grégoire Gaume
Grégoire Gaume
productividad
Director Técnico Aquactiva Solutions SL
Grégoire Gaume es Ingeniero Industrial de formación y tiene más de 15 años de experiencia en tecnologías ecoinnovadoras en tratamiento del agua y desinfección.
Durante 6 años, ha estado viviendo, trabajando y emprendiendo en países de Oceanía, Asia y Sudamérica con proyectos tecnológicos de impacto positivo a nivel medioambiental y social. Ha sido su principal escuela y fuente de inspiración.
Desde hace 10 años vive en Valencia, donde ha creado junto con 3 socios la empresa Aquactiva Solutions que comercializa equipos de agua electrolizada, un desinfectante altamente eficiente (hasta 80 veces más que la lejía), totalmente inocuo, muy rentable y producido únicamente a base de agua y sal.

El Ácido Hipocloroso (HOCl) es el desinfectante más eficaz, más inocuo, más ecológico y más antiguo que se conozca, ya que es producido naturalmente por nuestros glóbulos blancos para defendernos de cualquier patógeno (bacterias, hongos y virus). Este biocida, también llamado agua electrolizada, es altamente eficiente (hasta 100 veces más que el hipoclorito) y totalmente inocuo (clasificado como “no peligroso” según normativas REACH y CLP).
La tecnología patentada Aquactiva, electrolisis de membrana de última generación, permite producir in-situ un ácido hipocloroso ultrapuro (hasta 99%), a diferencia de otras tecnologías de electrolisis, usando únicamente agua y sal, a coste mínimo.
En granjas, este potente desinfectante se aplica para desinfectar el agua de bebida e higienizar el aire y superficies de las granjas mediante nebulización hasta en presencia de animales, al ser totalmente inocuo.
Aplicado en el agua de bebida, actúa como un potente biostimulante además de desinfectar el agua eliminando todo tipo de patógeno, biofilm e incrustaciones. Logra específicamente mejorar la calidad y la producción de los huevos:
1. reduce los huevos rotos, con grietas o sucios,
2. huevos más resistentes, uniformes y mejor calidad de la cáscara,
3. aumento de la producción de huevos y mayor masa por huevo,
4. aumento de la vida útil (elimina Staphylococcus, Salmonella y E. Coli en un tiempo récord),
5. reduce las bajas y los gastos veterinarios.
Aplicado en nebulización en presencia de animales, permite eliminar bacterias, hongos y virus tanto del aire como de las superficies, hasta en los puntos críticos de las naves. Se logra
así mantener higienizada las naves sin esperar a los vacíos sanitarios, mejorar considerablemente la salud de los animales, reducir enfermedad y bajas.
Ácido hipocloroso: desinfectante inocuo e higienizante con efecto bioestimulante que mejora la productividad de las aves
bioestimulante que mejora la productividad de

En industria alimentaria y procesado, se aplica para la limpieza y desinfección de instalaciones reemplazando hasta el 100% de desinfectantes y detergentes comerciales, reduciendo los tiempos de ciclos de lavado, canon de vertido y consumo de agua hasta un 50%, al usar productos inocuos que no requieren aclarados.
La tecnología Aquactiva ha sido instalada en más de 100 granjas en Europa donde se ha validado estos beneficios.
La empresa Aquactiva Solutions es una empresa Valenciana quien ha sido impulsada y financiada por programas como Lanzadera, Cajamar Innova, Climate-KIC (Comisión Europea), Scale The Impact (Danone) donde se ha validado la tecnología para el sector Ganadero y Agroalimentario junto con centros de investigación y universidades como el AINIA, Universidad de Valencia, Universidad de Gerona, Universidad Politécnica de Valencia, Universidad de Zaragoza, etc.


Nebulización de ácido hipocloroso Aquactiva en presencia de animales para eliminar hongos, bacterias y virus del aire y de las superficies.
Ácido hipocloroso: desinfectante inocuo e higienizante con efecto bioestimulante que mejora la productividad de las aves
efecto bioestimulante

Nebulizador ultrasónico de niebla seca y altamente eficiente para higienización con ácido hipocloroso.

Principales beneficios (en %) al utilizar la tecnología Aquactiva para procesos de limpieza y desinfección en industrias alimentarias.
Uso de productos químicos Tiempo laboral Consumo de agua Consumo de energía Costes de prevención laboral
Estándar Con Aquactiva
higienizante

Resultado de la calidad óptima del aire después de una nebulización con ácido hipocloroso Aquactiva.
desinfectante inocuo
Ácido



RECOMENDADO POR EMPRESAS DE LOS SECTORES PORCINO Y AVÍCOLA DE ESPAÑA
Sistema de gestión de ORP patentado y dirigido por ingenieros y veterinarios
+34 669 625 221
direccion@orpnovatio com
Guadalajara, España
www orpnovatio com
Sin patógenos y con niveles apropiados de pH y cloro libre asegurando el bienestar animal
ORP por encima de 750mV en toda la línea de agua de consumo de los animales durante los 365 días del año
“Cero” bacteriológico
Sin corrosión ni toxicidad
Una vez implantado el sistema otorgamos un periodo de 90 días para su verificación y aprobación
ORP NOVATIO
La nueva era en la desinfección del agua en granjas de puesta

José Antonio Martínez

José Antonio Martínez
Ingeniero de desarrollo e investigación en ORPNovatio y BIODYNA SL
J. A. Martínez Fereira, es Ingeniero en Investigación de Desarrollo en ORPNovatio con grados en Ingeniería en Producción Animal y Zootecnia.
Trabajó como Gerente de Operaciones Avícolas en Grupo EL Tunal y posteriormente se desempeñó como Delegado Regional en International Multifood.

En los últimos 10 años J. A. Martínez Fereira se ha dedicado con un equipo multidisciplinario al establecimiento de sistemas de bioseguridad en el agua, con las empresas Marketing Médico y Biodyna, a partir de las cuales se estableció el sistema ORPnovatio marcando “UNA NUEVA ERA EN LA DESINFECCIÓN DEL AGUA”
La desinfección tradicional del agua se ha venido realizando tomando en cuenta los ppm de cl y el pH. Sin embargo, en la nueva desinfección se exigen los parámetros de ppm de cl, pH, ORP (mV).
La OMS en su documento celebrado en Génova en el año de 1971 conjuntamente con la comunidad científica denominado International Standars for Drinking Water, estableció como parámetro necesario para la desinfección del agua de 650 mV de ORP.
El ORP del agua es la capacidad que tiene la misma de secuestrar electrones a la bacteria debido al oxígeno aportado lo cual impide la generación de ATP a nivel de las mitocondrias alterando el equilibrio iónico de las mismas, por lo tanto es imprescindible superar este valor para garantizar una plena desinfección del agua.
Bajo esta premisa ORPnovatio es un proyecto que ha desarrollado un conjunto de técnicas que permiten obtener umbrales de ORP iguales o superiores a los 650 mV en el agua de bebida de las aves y por consiguiente obteniendo un efecto de Cero microbiológico.
El método implantado por ORPnovatio se basa en la generación de una molécula metaestable, a través de equipos de alta tecnología debidamente legalizados tanto en España como en la EU.
Dicha molécula es aplicada en el agua de bebida con el fin de obtener 650 mV que permiten el efecto Cero microbiológico sin toxicidad y de muy baja corrosión, "todo material o sustancia es corrosivo dependiendo de cómo se maneje".


La nueva era en la desinfección del agua en granjas de puesta

El equipo generador controlado telemáticamente y conformado en su totalidad por piezas hechas en Europa, almacena la molécula de HCLO en un depósito en el cual es enviado a la red principal del agua de bebida de la granja por un sistema de bombas de alta tecnología.
El sistema controla que el agua de bebida de las gallinas al momento de ser ingerida sea biosegura y sin presencia de microorganismos.



Todo este sistema está concebido para ser verificado en sus valores de manera constante a través de la telemática, tanto en el funcionamiento del equipo generador, como en de la medición.
Es por todas estas características que hablamos de sistemas que forman parte de "La Nueva era de la desinfección del agua", con únicamente el ORP
La nueva era en la desinfección del agua en granjas de puesta





Bloque 4
Actualizaciones del manejo en sistemas alternativos
16:00 - 16:15

16:15 - 16:30
16:30 - 16:45
Control ambiental en los sistemas abiertos de puesta
Iluminación dinámica
multispectral y su influencia en el comportamiento y en la producción de las ponedoras alternativas
Importancia de la recría de pollitas en sistemas de aviarios para mejorar los rendimientos en la fase de producción

Serafín García Freire
Responsable técnico de avicultura en Boehringer Ingelheim. Conferencia ofrecida con el apoyo de CTIControl

Nice Hasani
Business Development Manager at ONCE Animal
Lighting by Signify IIG& Iberia

Mari van Gruijthuijsen
Business Development Manager Hellmann
16:45 - 17:15
Diálogo entre expertos:
Actualizaciones del manejo en sistemas alternativos
Bloque 5 - Medios e imagen ganadera
17:15 - 18:15
Los medios de comunicación y su impacto en la imagen social de la ganadería


- 20:00
y Divulgador


Serafín García Freire

Serafín García Freire
Responsable técnico de avicultura en Boehringer Ingelheim. Conferencia ofrecida con el apoyo de CTIControl
Veterinario, técnico superior de laboratorio de diagnóstico clínico y cursó el “Poultry Health Course” de patología aviar de la Universidad de Nottingham /Instituto Pirbright.
Fue veterinario de campo de recría/puesta de gallinas, de broilers, asesor internacional en control ambiental; operario en la cadenaasistente de calidad e inspector oficial en mataderos avícolas en Inglaterra, responsable técnico global de una farmacéutica (líder mundial en el antibiótico Fosfomicina) asesorando en campo sobre patologías aviares en el Sudeste asiático, Oriente medio, Latinoamérica y Rusia.
Actualmente es el responsable técnico de avicultura en Boehringer Ingelheim (España).

Una gallina produce 7 watios/hora de calor sensible. Si pensamos en una nave con 140.000 gallinas en jaula (código 3), con 0 oC de temperatura exterior y un aislamiento térmico de 5 cm de sándwich de poliuretano; necesitaríamos ventilar 136.000 m3/hora para alcanzar el equilibrio térmico de 21 oC en la nave. Si ventilamos menos subiría la temperatura en la nave y si ventilamos más bajaría la temperatura en la nave.
Ventilar 1 m3/hora/gallina para que la nave no suba de 21 grados, es un caudal suficientemente alto para tener en la nave una buena calidad ambiental (CO2, humedad y amoníaco bajo control).
En el momento que por “necesidades del mercado” tenemos que bajar las gallinas al suelo y reducimos el número de aves por nave; y todavía peor, abrimos aberturas de salida de las gallinas al exterior, entran otros muchos factores en juego que nos dificultan lograr que proporcionemos un adecuado confort térmico-ambiental a nuestras gallinas:
Mantener la temperatura de confort en la nave.
Evitar que las corrientes del aire frío exterior incidan directamente en las aves.
Mantener la uniformidad térmico-ambiental a lo largo de la nave, evitando zonas hiper-hipoventiladas o corrientes de aire. Las aves se mueven por la nave buscando o evitando evitando estas zonas, lo que puede ocasionar amontonamientos y asfixias.
Mantener la cama suficientemente seca para que las aves no tengan pododermatitis y no se enfríen por tener la cama “fría”.
Mantener el ambiente suficientemente húmedo para que las partículas de polvo se hidraten y no tengamos un exceso de polvo ambiental en suspensión.
En naves con salidas a parque, proporcionar una adecuada velocidad de aire para enfriar la sensación térmica de las gallinas.
En los sistemas de jaulas el control ambiental es mucho más preciso y eficiente; y el confort térmicoambiental de las gallinas es mucho más fácil de conseguir.
Los sistemas de suelo suponen un gran cambio en el manejo, que requieren asesoramiento, instalaciones adecuadas, formación y mucha más dedicación.

El confort térmico-ambiental de las aves es muy rentable
(Ver Gráfico 1 y 2).

En aviarios con salida a parque sin producción en ecológico
En ventilación de invierno:
Las instalaciones y equipamientos requeridos son los mismos que para naves sin salida a parque. Habría 2 opciones:
1 2
Ventilación longitudinal y entrada de aire mediante trampillas laterales (muy recomendable el techo liso sin correas) y
La ventilación cenital con chimeneas de entrada de aire mezcladoras (que mediante una válvula que varía el porcentaje de abertura, mezcla aire frío exterior con el aire interior).
Cada una de estas opciones tienen sus ventajas y sus inconvenientes; y en función del tipo de producción, climatología y características de la nave, será más o menos apropiado una opción u otra; pero en ambos sistemas, es altamente recomendable que entre la jaula/aviario/ ponedero y el techo haya 1,5 metros como mínimo (óptimo 2-2,5 metros), para evitar corrientes de aire del exterior incidiendo sobre las aves.
Durante el periodo de tiempo que las compuertas de salida a parque están abiertas, en la nave se produce una ventilación natural a través de estas compuertas (la ventilación longitudinal queda limitada).
Las funciones que debería tener un ordenador de gestión ambiental para gestionar eficientemente la ventilación mínima son:
Ventilación mínima según el “coeficiente de ventilación mínima”: m3/hora/kg de peso o m3/hora/ave.
Que este “coeficiente de ventilación mínima” sea corregido cuando haya:
Exceso de humedad interior (aumentando de forma progresiva el “coeficiente de ventilación mínima”).
Niveles altos de CO2 (aumentando de forma progresiva el “coeficiente de ventilación mínima”).
Temperatura interior baja (disminuyendo de forma progresiva el “coeficiente de ventilación mínima”).
Control remoto del ordenador.
En ventilación de verano:
El sistema de ventilación túnel (entradas de aire por un extremo de la nave y extractores en el otro extremo) sigue siendo recomendable, aunque durante el periodo de tiempo que las compuertas de salida a parque están abiertas, la mayor parte del aire entra por estas compuertas, la velocidad de aire en la nave es menor y la eficiencia de enfriamiento del sistema “ventilación túnel + panel evaporativo” es mucho menor.
En ventilación de invierno:
En granjas con producción ecológica, es obligatorio la ventilación natural de forma permanente (Reglamento Europeo 848/2018); por tanto, la ventilación forzada sólo puede suplementar esa ventilación natural.
Dispondremos de ventanas a ambos lados de la nave con la precaución de ventilar cumpliendo la regla de 1 x 4 (abriendo menos por donde incide el viento);
Además para reducir al máximo el efecto pernicioso del viento frío al nivel de las aves, sólo deberían de abrir las compuertas de salida a parque del lateral contrario al viento dominante en ese momento.
El ordenador de control ambiental puede reducir la influencia, en la nave, de las condiciones climatológicas adversas, si dispone de estas funciones:
Que la ventilación mínima pueda ser programada por el avicultor fijando las “aperturas mínimas de ventanas” según la edad, la climatología, etc.
Que estas “aperturas mínimas de ventanas” sean corregidas cuando haya:
Exceso de humedad interior (aumentando la apertura de las ventanas).
Temperatura interior baja (disminuyendo la apertura de las ventanas).
Control remoto del ordenador

Evitar el sol directo en la nave, instalando telas sombreadoras, ampliando el alero de la nave.
Facilitar la salida al exterior de las gallinas (y así reducir la temperatura en la nave), se recomienda la instalación de refugios o creación de sombras en el parque.
En zonas cálidas y con poca humedad exterior, con el objetivo de reducir la temperatura en la nave, es recomendable complementar la ventilación natural con la instalación de cabinas de impulsión con paneles evaporativos.




comportamiento y en la producción
Nice Hasani
Business Development
Manager at ONCE Animal
Lighting by Signify IIG& Iberia
Business Development Manager at ONCE
Animal Lighting by Signify IIG& Iberia
Su carrera comenzó en 1984, cuando se desempeñó como técnico de reproducción en un centro de selección genética de cerdos.
En 1995, tuvo la oportunidad de empezar a colaborar con una reconocida empresa fabricante de equipos Avícolas (Facco Poultry Equipment), experiencia que le permitió profundizar en el Departamento de Ciencia y Tecnología Avícola.

Después de acumular una valiosa experiencia en este campo, Nice fue designado misionero de Facco Poultry Equipment, una responsabilidad que lo llevó a viajar por América Latina para difundir tecnologías avanzadas en la industria avícola. Durante esta etapa, Nice no solo se convirtió en un experto en fonética y español, sino que también añadió una década de experiencias enriquecedoras a su vida profesional.
Hace tres años, su trayectoria dio un giro significativo cuando un cazatalentos le presentó la oportunidad de explorar el sector de la iluminación aplicada a los animales y la acuicultura en Signify, conocida anteriormente como Philips Lighting, el segundo proveedor de soluciones de iluminación más grande del mundo, superado solo por el sol.
Hoy, Nice se encuentra aquí para comparti, las lecciones aprendidas y las experiencias acumuladas a lo largo de sus 30 años de carrera en avicultura, con especial énfasis en sus últimos tres años en el innovador mundo de la iluminación aplicada a la avicultura en ONCE by Signify.
En la avicultura moderna, la iluminación se ha convertido en una de las herramientas más potentes para gestionar y optimizar el rendimiento de las ponedoras. La iluminación tiene un profundo impacto en la producción, la salud y el bienestar general.
Tanto si se trata de aviario multi-piso como de un sistema aviario de suelo, el enfoque de iluminación adecuado puede mejorar drásticamente los resultados.
Entre las tecnologías de iluminación más avanzadas, NatureDynamics se destaca como una solución pionera que adapta la programación del fotoperiodo, el espectro, la intensidad y la distribución de la luz a las necesidades biológicas de la ponedora.
Este artículo explica cómo el sistema de iluminación NatureDynamics puede transformar la gestión de las gallinas ponedoras a través de soluciones respaldadas por la ciencia.
luz
La iluminación juega un papel fundamental en el control de las respuestas fisiológicas y conductuales de las aves. Hay cuatro aspectos principales de la iluminación que deben optimizarse para manejar las aves de manera efectiva: programación, espectro, intensidad y distribución
Programación
La programación se refiere al tiempo y la duración de la exposición a la luz.
Esto incluye el fotoperiodo, o el número de horas de luz que recibe un ave en un ciclo de 24 horas.
El fotoperiodo correcto ayuda a sincronizar el ritmo circadiano del ave con las señales ambientales, lo cual es crucial para las funciones reproductivas y metabólicas.
Iluminación dinámica multispectral y su influencia
Iluminación dinámica multispectral y su influencia en el comportamiento y en la producción de las ponedoras alternativas
Espectro
El espectro involucra las longitudes de onda de la luz percibida por las aves.
Las diferentes longitudes de onda tienen efectos biológicos distintos, y las aves responden a la luz de manera diferente en varias etapas de la vida.
Intensidad
La intensidad se refiere a la intensidad con la que se percibe la luz, lo que influye en el comportamiento y los procesos biológicos.
Distribución
La distribución se refiere a la uniformidad con la que se distribuye la luz en un aviario o sistema, lo que puede tener un impacto directo en el comportamiento de las aves y los patrones de puesta de huevos.
Para las gallinas ponedoras, la integración de estos cuatro factores es vital. Cuando se hace correctamente, la iluminación optimiza su fisiología reproductiva, mejora la función inmunológica y mejora la producción de huevos. Comprender los principios científicos detrás de la iluminación es esencial para desarrollar un sistema que beneficie tanto la salud como la productividad del lote.
Para las gallinas ponedoras, las longitudes de onda rojas juegan un papel fundamental en el manejo de los ciclos reproductivos.
Las aves son únicas en el sentido de que pueden percibir la luz tanto a través de sus ojos como a través de regiones cerebrales especializadas, como el hipotálamo y la glándula pineal.
La luz roja, específicamente, penetra en el cráneo y llega a estas regiones, ayudando a regular la producción de melatonina.
La melatonina es una hormona que influye en los ritmos circadianos, los niveles de hormonas reproductivas e incluso la función inmunitaria.

Los niveles de melatonina circulan durante el día según el ritmo día/noche. La melatonina se produce durante la fase oscura y se reduce durante la fase diurna. Por lo tanto, el fotoperiodo, o la duración de la luz del día, influye fuertemente en los niveles de melatonina circulante.
La melatonina inicia una cascada hormonal que, a su vez, regula la producción de gonadotropina, que controla el desarrollo sexual y el inicio de la puesta de huevos.
Las reproductoras de día largo, como las gallinas, dependen de períodos prolongados de luz para iniciar la producción de huevos, lo que hace que el manejo del fotoperiodo sea esencial en un sistema de iluminación.
Al simular el alargamiento de los días de primavera, NatureDynamics es capaz de estimular la producción de huevos de forma natural y saludable. Este proceso, conocido como foto-estimulación, asegura que las gallinas comiencen a poner en el momento óptimo sin entrar prematuramente en etapas reproductivas.
Durante la fase de pollitas, se utiliza iluminación de día corto para apoyar el crecimiento y retrasar la madurez sexual, lo que garantiza una transición suave a la etapa de puesta cuando es el momento adecuado.
Los desafíos únicos de los sistemas aviarios
Los sistemas de aviarios (sin jaulas) ofrecen a las aves más libertad de movimiento, lo que puede presentar desafíos únicos para el manejo del grupo de ponedoras.
Uno de los problemas más importantes es garantizar que las aves se distribuyan uniformemente por el espacio tridimensional, ya que el hacinamiento o el agrupamiento pueden provocar comportamientos negativos como el amontonamiento o el picoteo de las plumas.
Además, las gallinas en estos sistemas son propensas a poner huevos en el suelo si no tienen señales claras que las guíen a las áreas de anidación.


NatureDynamics aborda estos desafíos a través de su control dinámico de la distribución de la luz. Mediante el uso de controles de atenuación independientes para cada área y nivel del sistema, NatureDynamics puede alentar a las aves a moverse a diferentes áreas en diferentes momentos del día.
Iluminación dinámica multispectral y su influencia en el comportamiento y en la producción de las ponedoras alternativas
Por ejemplo, durante el período de anochecer, las luces por debajo del sistema se pueden atenuar primero, lo que alienta a las aves a moverse hacia arriba y posarse en perchas más altas.
El atenuamiento gradual durante un período de 30 minutos imita una puesta de sol natural, lo que les da tiempo a las aves para encontrar una percha cómoda y acomodarse para pasar la noche.
Este proceso de atenuación gradual no solo mejora la distribución de las aves, sino que también ayuda a reducir la incidencia de huevos en el suelo en un 8 %. Mediante el uso de una iluminación más brillante y fría en áreas abiertas y una luz más tenue y enriquecida con rojo en los espacios de anidación, las gallinas son guiadas naturalmente para poner en las áreas apropiadas.
Este nivel de control garantiza que tanto el bienestar de las aves como los objetivos de producción se cumplan simultáneamente.
El espectro de luz utilizado en los sistemas de iluminación avícola puede variar significativamente según la edad y la etapa del ave.
Una investigación realizada por la Universidad de Wageningen en colaboración con Signify ha demostrado que los pollos y las pollitas tienen diferentes preferencias espectrales en diferentes etapas de la vida.
Durante la incubación, los polluelos prefieren la luz rica en longitudes de onda rojas, lo que favorece su desarrollo temprano.
A medida que maduran, su preferencia cambia hacia las longitudes de onda azul y verde, que promueven comportamientos de búsqueda de alimento y exploración.
Al final, una vez que alcanzan la madurez sexual, las pollitas maduras vuelven a preferir la luz enriquecida con rojo, que apoya los comportamientos de puesta de huevos.
NatureDynamics aprovecha estas preferencias cambiantes al ofrecer soluciones de iluminación totalmente personalizables que ajustan el espectro de luz en función de la etapa de desarrollo de las aves.
Durante la incubación, el sistema proporciona una luz cálida y rica en rojo, que luego se puede ajustar gradualmente a longitudes de onda más frías durante la etapa de pollita. A medida que las gallinas pasan a la puesta, el sistema vuelve a un espectro tenue y enriquecido con rojo que promueve los comportamientos de anidación y oviposición.

Iluminación dinámica multispectral y su influencia en el comportamiento y en la producción de las ponedoras alternativas
Manejo del estrés y del picoteo de plumas a través de la luz dinámica
Uno de los problemas más comunes y problemáticos en el manejo de un grupo de ponedoras en aviario es el picoteo de las plumas, un comportamiento que puede intensificarse rápidamente y provocar lesiones graves o incluso la muerte.
El estrés es uno de los principales desencadenantes del picoteo de las plumas, y la luz desempeña un papel en la exacerbación o el alivio de este comportamiento.
NatureDynamics ofrece una solución eficaz para controlar los comportamientos relacionados con el estrés, como el picoteo de las plumas, a través de su tecnología de atenuación a rojo.
Cuando las aves se vuelven demasiado agresivas o estresadas, atenuar las luces y cambiar a un espectro rojo puede ayudar a calmar a la parvada.
La luz roja enmascara los estímulos visuales, como sangre o llagas, lo que reduce el picoteo adicional, mientras que la iluminación tenue reduce los niveles generales de actividad. Una vez que el problema está bajo control, el sistema puede volver gradualmente a una luz más brillante y de espectro completo.

influencia
y
NatureDynamics se diferencia de los sistemas de iluminación tradicionales por su flexibilidad sin igual. En esencia, el sistema utiliza canales independientes rojo, verde/blanco y azul, cada uno de los cuales se puede atenuar o iluminar según las necesidades del lote.
El sistema de control inalámbrico Zigbee permite asignar cada dispositivo de luz a diferentes zonas, lo que brinda al avicultor un control total sobre la distribución de la luz, la programación y el espectro en cada área del aviario. Este nivel de control es esencial para adaptarse a las necesidades siempre cambiantes del lote.
Por ejemplo, durante los períodos de mucho calor, los avicultores pueden ajustar la intensidad y el espectro de la luz para fomentar niveles de actividad más bajos y reducir el calor producido por las aves.
Durante la despoblación, se ha demostrado que el cambio a la luz azul monocromática reduce el aleteo y el estrés, lo que hace que el proceso sea más suave tanto para las aves como para los avicultores.


En la industria avícola actual, optimizar la producción, la salud y el bienestar de las ponedoras requiere un enfoque dinámico de la iluminación.
NatureDynamics no es solo otro sistema de iluminación, NatureDynamics es una solución integral que integra las últimas investigaciones en biología avícola con tecnología de vanguardia.
Al adaptar la programación de luz, el espectro, la intensidad y la distribución a las necesidades de la parvada, NatureDynamics ofrece a los avicultores un control sin precedentes sobre sus operaciones.
Ya sea para reducir el estrés, prevenir los huevos en el suelo u optimizar el rendimiento reproductivo, este sistema de iluminación dinámica cambia las reglas del juego para la industria.
A través de NatureDynamics, no solo estamos iluminando las naves avícolas, estamos iluminando el futuro de la gestión avícola.



PRO-MOTION: Sistema de recría de pollitas
Sistema diseñado para estimular los movimientos naturales de las aves (saltar, caminar, volar ….)
Produce pollitas más fuertes y desarrolladas
Plataformas móviles y líneas de agua ajustables
Las puertas se abren manualmente, permitiendo que las aves puedan estar más tiempo en el sistema, facilitando manejo y vacunaciones.
Facilita la adaptación de las pollitas al tipo de producción en aviario, disminuyendo la puesta en suelo.
Importancia de realizar la recría de pollitas en sistema aviario para optimizar los rendimientos en su fase de producción y minimizar la puesta en suelo.


PRO-11: Sistema de aviario en puesta
Sistema diseñado para minimizar al puesta en suelo y en otros lugares del aviario
Nidales con un único sistema de expulsión que evitan que tanto las aves como los huevos permanezcan tras su cierre
Lineas de bebida frente anidales
Cadenas de alimentación con sistema antiderrame en toda la canal
Iluminación led dinámica tanto en el sistema como debajo del mismo.
CONTACTOS: OFICINA: 938 29 04 20
MOVIL: 621 24 20 26

Mari van Gruijthuijsen

Mari van Gruijthuijsen
Business Development Manager Hellmann
Mari van Gruijthuijsen (1962) ha trabajado en la industria avícola desde 1995. Desde entonces, ha trabajado para múltiples fabricantes de instalaciones avícolas y ha implementado equipos en cientos de granjas en todo el mundo, en todo tipo de condiciones y diseños. Tanto para granjas pequeñas como muy grandes, para propietarios familiares, así como para integradores. La posición actual de Mari es gerente de desarrollo de negocios para el fabricante de instalaciones avícolas Hellmann Poultry, con sede en Vechta, Alemania.

Durante mi presentación, voy a mostrar ejemplos de la "próxima generación" de sistemas de aviario para la recría de pollitas y lo que esto significa tanto para el recriador de pollitas como para la cadena de producción de huevos.
Si retrocedemos a los inicios de la producción de huevos en sistemas alternativos a las jaulas en Europa, recordaremos las significativas pérdidas de huevos y el excesivo tiempo invertido cuando las aves no eran recriadas de manera profesional en aviarios.
Esto sucedía porque las ponedoras no estaban entrenadas para moverse en los sistemas aviarios; como resultado, permanecían en el suelo por la noche y ponían huevos en el suelo y/ o dentro del sistema, es decir, en cualquier lugar menos en los nidos.
Debido a esto, los productores dedicaban mucho tiempo al proceso de acostar las aves —moviendo las aves al sistema por la noche—, recogiendo huevos del suelo y del sistema, y sufriendo pérdidas por aquellos huevos que ni siquiera se encontraban o que estaban rotos y/o sucios.
Esto comenzó a mejorar cuando se empezaron a utilizar los primeros sistemas en el suelo con plataformas móviles, seguidos por los sistemas de recría en aviario.
Estos sistemas de recría en aviarios de primera generación ofrecían mucha capacidad adicional por nave, pero solo empezaban a enseñar a las pollitas a saltar y volar después de que eran liberadas al suelo
En conclusión, debemos decir que la producción de huevos en aviario es imposible sin una recría profesional de pollitas en aviario.

Importancia de la recría de pollitas en sistemas de aviarios para mejorar los rendimientos en la fase
El reto es enseñar a las pollitas a saltar y volar desde el día en que entran al sistema de recría, es decir, desde que las pollitas tienen un día de vida. Esto requiere un diseño completamente nuevo del sistema de recría anterior.
En mi presentación, mostraré un video que explica la disposición de este sistema y la interacción con las aves.
Permítanme describirlo de la siguiente manera:
El sistema de recría de pollitas de última generación está equipado internamente con un suelo de plataforma móvil.
Desde el primer día, este suelo de la plataforma móvil, al igual que todos los bebederos, está en el nivel más bajo.
Sin embargo, muy pronto, los bebederos comienzan a elevarse, y lo mismo sucede con la plataforma elevable.
Esto significa que las aves ya están siendo motivadas a saltar y volar, moviéndose dentro del sistema a una edad muy temprana, y mucho antes de ser soltadas en el suelo.

Las diversas líneas de bebederos móviles se utilizan como una herramienta para un entrenamiento muy importante, ya que encontrar las líneas de agua será crucial más adelante, en la fase de producción de huevos, para localizar los nidos donde poner los huevos.
En estos nuevos sistemas, verás que ya en el día 10/11, las primeras aves comienzan a usar el nivel interno más alto del sistema de recría. Este nivel es comparable al nivel superior de las perchas en la nave de producción.
Durante las semanas iniciales dentro del sistema, tanto los bebederos como la plataforma se elevan conforme al crecimiento corporal de las pollitas, entrenando continuamente a las aves para alcanzar niveles más altos dentro del sistema, como tendrán que hacer en la nave de puesta.
Este enfoque ofrece, por supuesto, un entrenamiento 24/7 de las aves, resultando en pollitas más fuertes que tienen un mejor rendimiento más adelante cuando entran al sistema de producción ya en la nave de puesta.
Importancia de la recría de pollitas en sistemas de aviarios para mejorar los rendimientos en la fase

Además, se ahorra mucho en mano de obra, ya que las aves entran al sistema en un solo nivel (más espacioso) en lugar de múltiples niveles cerrados, como ocurría en sistemas de aviario más antiguos.
Asimismo, este nuevo sistema de aviario, ofrece una forma mucho más sencilla de vacunar a las aves al tenerlas dentro de una gran sección.
Adicionalmente, las aves pueden mantenerse aproximadamente 3 semanas más dentro del sistema, ya que están saltando y volando dentro de él. Esto es una ventaja adicional para la gestión. Especialmente en las primeras 9 a 10 semanas de la fase de recría donde la mano de obra se reduce en un 50 a 55% con este nuevo sistema.
Por lo tanto, el mejor entrenamiento de las aves es esencial para el resto de la cadena de producción de huevos. Pero además de un mejor entrenamiento y una gestión más fácil, ¿qué significa esto para el ciclo de recría? La experiencia nos ha mostrado los siguientes puntos importantes:
Mayor densidad de aves por nave, lo que garantizar un mayor número de pollitas recriadas para la venta. Los sistemas de última generación pueden albergar hasta un 20% más de aves.
Reducción de la mortalidad, con una disminución de hasta 1 punto porcentual en comparación con las generaciones anteriores de aviarios
Menos acumulación de gallinaza en el suelo, ya que los aseladeros están integrados dentro del sistema en lugar de estar fuera, como en los diseños anteriores.
Este sistema de aviario de última generación, más automatizado, requerirá una inversión ligeramente mayor en comparación con los sistemas anteriores. Sin embargo, el aumento en la producción de aves, junto con el ahorro en mano de obra, permitirá un rápido retorno de la inversión, generando ingresos y ahorros adicionales para el recriador de pollitas a lo largo de los 25 a 30 años de vida útil del equipo.
Para el productor de huevos, estos sistemas ofrecen aves mucho mejor entrenadas, con menos huevos en el suelo y en el sistema. Además, las aves mejor entrenadas se comportarán de manera más eficiente dentro de la nave de puesta, reduciendo también la acumulación de gallinaza en el suelo.
Para los productores de huevos, recibir aves recriadas en estos sistemas de última generación será una gran ventaja.

Estas experiencias se basan en datos generados por Hellmann Poultry, de Vechta, Alemania, y provienen de granjas comerciales reales. Se puede obtener más información enviando un mensaje a mvangruijthuijsen@hellmannpoultry.de o al móvil/Whatsapp +31 642733323. Hellmann está representada en España por Agrener. Los especialistas avícolas de Agrener pueden ser contactados en el 93 829 04 20 o agrener@agrener.com.
aviforum.info
Importancia de la recría de pollitas en sistemas de aviarios para mejorar los rendimientos en la fase de producción

Disponible en dos anchos diferentes y combinables en una misma nave
100% de la puesta en el sistema en una misma cinta

NUEVA CINTA
de huevos con mayor capacidad

Dos niveles de nidal para una mejor distribución de las aves durante las horas de puesta, permitiendo un reparto uniforme de la producción

Bloque 6 – Patología en avicultura de postura
09:30 - 10:15

10:15 - 10:30
10:45 - 11:00
Actualizaciones sobre el Mycoplasma synoviae
Casos prácticos de vacunación con vacunas inactivadas de Mycoplasma

Jose B. Poveda Guerrero
Catedrático de Universidad de Las Palmas de Gran Canaria- ULPGC

Sergio Merinero Martín Agricultural Engineer UPM
11:15- 11:30 11:00- 11:15
11:30 - 11:45
10:30 - 10:45 11:45 - 12:30
Virus de la bronquitis infecciosa (IBV), hallazgos, diagnóstico y soluciones
¿Por qué vacunar frente a Salmonella Enteritidis durante la puesta?
La vacuna viva bivalente de Salmonella en avicultura de puesta
Autovacunas en avicultura: situación actual y ejemplos prácticos

Jordi Serra Martínez
Sales Manager SANVET / Estudio de la Dra. Kathrin Schulze Bernd

Pablo Soler Romero
Servicios Técnicos
Avicultura España Calier


Uso racional de antibióticos en avicultura de puesta: eficacia y sostenibilidad

12:30 - 13:15
Félix Ponsa
Technical Consultant de avicultura en Elanco Iberia
Ana Fernández, DVM PhD Responsable del Departamento de Autovacunas del Laboratorio veterinario Exopol

Claudio Chimienti
DMV – VET&SPHERE
Reseau Cristal Francia
COFFEE BREAK
Diálogo entre expertos: Patología en avicultura de postura
Bloque 7 – Avicoloquio: “Toda una vida en el sector”
13:15 - 14:00
Entrevista con José Pedro Sacristán

José Pedro Sacristán
Managing Director Spain. LOHMANN-BREEDERS Spain

Jose B. Poveda Guerrero

Prof. Dr. Jose B.
Poveda Guerrero
Catedrático de Universidad de Las Palmas de Gran Canaria- ULPGC
Catedrático de Universidad en activo en el área de Sanidad Animal desde 2003, adscrito al Departamento de Patología Animal y al Instituto Universitario de Sanidad Animal y Seguridad Alimentaria (IUSA) de la Universidad de Las Palmas de Gran Canaria.
Es Licenciado en Veterinaria (1983) y Doctor en Veterinaria por la Universidad de Córdoba (1988). Realizó su tesis doctoral sobre micoplasmas aviares, describiendo tres nuevas especies de estos microorganismos (Mycoplasma buteonis, Mycoplasma falconis y Mycoplasma gypis). Entre 1988 y 1989 realizó sus estudios de postgrado en el Instituto de Microbiología y Enfermedades Infecciosas de la Escuela Superior de Veterinaria de Hannover, bajo la dirección de la Profesora Helga Kirchhoff. Su trabajo postdoctoral se centró sobre micoplasmas aviares.

Es investigador en activo en el Instituto Universitario de Sanidad Animal y Seguridad Alimentaria (IUSA) de la ULPGC, y jefe de la División de Epidemiología y Medicina Preventiva del mencionado instituto.
Ha publicado más de 100 artículos en revistas científicas indexadas en el Journal of Citation Reports, la mayor parte de ellos referidos a micoplasmas-micoplasmosis, y ha participado en más de 150 comunicaciones a congresos, la mayor parte de ellas internacionales.
Mycoplasma synoviae es uno de los patógenos más importantes en avicultura, y representa una amenaza para la salud avícola, generando pérdidas económicas importantes en la industria avícola mundial.
Mycoplasma synoviae causa sinovitis infecciosa en pollos y en pavos, enfermedad descrita por primera vez en EEUU al principio de la década de los 50.
Los signos clínicos de la infección por Mycoplasma synoviae dependen del tropismo y de la virulencia de las distintas cepas.
En la década de los 50-60 y 70, predominaron los cuadros de sinovitis infecciosa. En la década de los 80, aparecieron cepas de tropismo respiratorio.
La mayor parte cursan como una infección respiratoria superior subclínica, pero se pueden observar signos clínicos y lesiones más graves, cuando estas cepas se asocian con Escherichia coli, virus de tropismo respiratorio, tanto vacunales, como de campo, de la enfermedad de Newcastle, o de la bronquitis infecciosa, e incluso con virus que pueden causar inmunosupresión, como el virus de la bursitis infecciosa.
Las anormalidades del ápice de la cáscara del huevo “eggshell apex abnormalities” (EAA) se describieron por primera vez en ponedoras ligeras blancas alojadas en jaula, alrededor de los 2000, pero más tarde se observaron en ponedoras de huevos marrón y en diferentes tipos de producción.
Feberwee y colaboradores describieron y demostraron en 2009, la asociación entre la presencia de Mycoplasma synoviae en el oviducto, y la producción de huevos con anomalías del ápice de la cáscara (EAA).
Este síndrome, se caracteriza por una superficie de la cáscara alterada, adelgazamiento de la cáscara, mayor translucidez (detectable macroscópicamente, particularmente en la ovoscopia y la aparición de grietas y roturas.
Las lesiones de la cáscara del huevo se limitan a una región de aproximadamente 2 cm desde el ápice (cono superior del huevo). Esta alteración se ve exacerbada por la asociación de Mycoplasma synoviae y el virus de la bronquitis infecciosa.
La infección endémica en granjas de ponedoras comerciales persiste debido a la transmisión vertical y horizontal de Mycoplasma synoviae.
La formación de biopelículas puede facilitar la persistencia de estos microorganismos fuera de las aves, y condicionar la epidemiología.
Esta propiedad se ha evidenciado en todas las especies de micoplasmas aviares, excepto en Mycoplasma iowae
En general, los micoplasmas patógenos, producen mayores cantidades de biopelículas en comparación con los no patógenos.
Además, la capacidad de producir biopelículas varía tanto cualitativa como cuantitativamente, no sólo entre diferentes especies sino también entre aislamientos de una misma especie.
Mycoplasma synoviae tiene la capacidad de producir in vitro películas que se evidencian en los medios líquidos, y cristales en los medios sólidos (film and spot production).


En algunos continentes, la seroprevalencia de Mycoplasma synoviae supera el 70% en las granjas de ponedoras, y la relevancia clínica y económica de este microorganismo, es superior a la de Mycoplasma gallisepticum.
Sin embargo, la patogenia y los posibles factores de virulencia de Mycoplasma synoviae, aún no se conocen por completo.
La adhesión y la producción de peróxido de hidrógeno por parte de los micoplasmas, son factores claves para la virulencia.
La adhesión a las células se reconoce como el principal requisito para la infección y la colonización.
La pérdida de la capacidad de adhesión por pases repetidos en medios de cultivo conduce a la pérdida de infectividad, mientras que la reversión al fenotipo adherente por pases en aves o en huevos embrionados, se acompaña por la recuperación de la infectividad y la virulencia.
Por lo tanto, las adhesinas juegan un papel importante en la determinación de la virulencia de los micoplasmas.
Recientemente, se describió una nueva adhesina en Mycoplasma synoviae (LP78), se trata de una proteína de adhesión de unión a fibronectina/plasminógeno, que puede servir además como un antígeno de diagnóstico potencial.
Las herramientas de control de la infección por Mycoplasma synoviae incluyen medidas de bioseguridad, el monitoreo, el diagnóstico, la terapia con antibióticos, y la vacunación con vacunas comerciales vivas atenuadas, inactivadas y autovacunas.


El equilibrio óptimo para una microbiota intestinal saludable y un bienestar sostenible



La mezcla única de monoglicéridos de ácidos butírico, caprílico y cáprico de origen natural.
Mantiene el equilibrio de la microbiota
Promueve la digestión y nutrición
Mejora la integridad intestinal
Fomenta la salud y la vitalidad

Para más información: AlbioFerm, S.L. T. 937 291 764 phalbio@phalbio.com www.phalbio.com Distribuido por The science of sustainable feed that succeeds


nutricion.animal@basf.com animal-nutrition.basf.com
*Apoya a las bacterias beneficiosas además de los efectos positivos del ácido butírico en la mucosa intestinal. Consigue mayores resultados productivos en granja de manera sostenible.






En los últimos años, debido a la creciente importancia de Mycoplasma synoviae y su impacto en la producción avícola, se ha llevado a cabo la implementación
de programas voluntarios de control de este microorganismo.
Estos programas de control, con frecuencia se han basado en la experiencia previa de erradicación de Mycoplasma gallisepticum de las parvadas de reproductoras. No obstante, a diferencia de Mycoplasma gallisepticum, la prevalencia de la infección por Mycoplasma synoviae continúa siendo alta en todo el mundo.


Además de la bioseguridad, la vacunación es importante para el control de Mycoplasma synoviae, ya que se ha demostrado que contribuye a la reducción del impacto económico y, experimentalmente, también disminuye la transmisión horizontal.
La vacuna viva atenuada MS-H (Vaxsafe MS-H, BioProperties Pty. Ltd. Australia), es la más comúnmente utilizada en todo el mundo para el control de Mycoplasma synoviae
Esta cepa tiene un fenotipo sensible a la temperatura (TS+), que se obtuvo por mutagénesis utilizando N-MetilN'-Nitro-Nitrosoguanina) (Markham et al., Morrow et al.)
Los cultivos sensibles a la temperatura se definen como aquellos que tienen un título inferior cuando se cultivan a 39.5 °C en comparación con 33 °C.
En un estudio de campo, (Markham y colaboradores en 1998) mostraron que el 18% (9/50) de los reaislamientos de la cepa de la vacuna MS-H, habían perdido su fenotipo sensible a la temperatura y habían cambiado al fenotipo insensible a la temperatura.
La otra cepa viva atenuada que se emplea en muchos países para el control de Mycoplasma synoviae es la cepa vacunal MS1 independiente del B-NAD (Nobilis MS Live, MSD Health Sudáfrica).
Al utilizar una cepa viva atenuada, es imprescindible que la misma tenga capacidad suficiente para producir una inmunidad protectora durante todo el ciclo de puesta de las ponedoras industriales, sin revertir al fenotipo de campo.
Gran parte del diagnóstico actual en avicultura industrial se basa en la diferenciación de las cepas de campo de Mycoplasma synoviae y aquellas que proceden o derivan de las cepas vacunales y que han vuelto al fenotipo de campo.
En condiciones experimentales y de campo, se demostró que las vacunas vivas de Mycoplasma synoviae no impiden la colonización de las cepas de campo, pero reducen su diseminación,
Estos resultados también sugieren el potencial de las vacunas vivas para reemplazar a las cepas de campo, algo que todavía no ha sido observado con Mycoplasma synoviae, pero no se excluye que un porcentaje de las vacunas vivas revierta al fenotipo de campo, después de una serie de pases en aves, como han observado algunos investigadores.
Aún quedan por explorar las distintas combinaciones de vacunas vivas e inactivadas, e incluso autovacunas, para conseguir la protección en el ciclo completo de las ponedoras comerciales.

investigación entre 2014-2024. (Poveda y col., datos sin publicar).

es cuestión suerte
Investigamos y testeamos nuestros productos para no dejar nada al azar.
Investigamos y testeamos nuestros productos para no dejar nada al azar.
Investigamos y testeamos nuestros productos para no dejar nada al azar.
Investigamos y testeamos nuestros productos para dejar nada al azar.

empresa en crecimiento
Una empresa en crecimiento

empresa en crecimiento
Vacuna inactivada de Mycoplasma synoviae registrada para aves.
• Previene mortalidad y reduce síntomas clínicos provocados por MS.
• Inmunidad antes del inicio de la puesta.
• Inmunidad durante al menos 42 semanas.
• Dosis 0,5 ml.
967

Vacuna inactivada de Mycoplasma gallisepticum registrada para aves.
Una empresa en crecimiento
PROVETSA distribuye a nivel español algunas de las marcas más prestigiosas del mercado y con amplia presencia en el botiquín de los veterinarios.
Contamos con una amplia red de colaboradores.
PROVETSA distribuye a nivel español algunas de la marcas más prestigiosas del mercado y con amplia presencia en el botiquín de los veterinarios.
PROVETSA distribuye a nivel español algunas de las marcas más prestigiosas del mercado y con amplia presencia en el botiquín de veterinarios. Contamos con una amplia red de colaboradores.
Contamos con una amplia red de colaboradores.
PROVETSA distribuye a nivel español algunas de las marcas más prestigiosas del mercado y con amplia presencia en el botiquín de los veterinarios. Contamos con una amplia red de colaboradores.
Agrocid Alimento para • Acidificante • Reducción •
SALUD salud
967
• Previene mortalidad y reduce síntomas clínicos provocados por MG.
Poblaciones +3000
• No interfiere en el crecimiento.
Poblaciones +3000
• Dosis 0,5 ml.
Poblaciones +3000
• Protección durante al menos 12 meses.
M2 Almacenajes +1500
M2 Almacenajes +1500
M2 Almacenajes +1500
Referencias +55
Referencias +55
Empleados
Referencias +55
Empleados
Empleados

Sergio Merinero Martín

Sergio Merinero Martín CEO de Nuvet Agriservices
Agricultural
Engineer UPM
3 años de experiencia como genetista en Hendrix Poultry Breeders -Holanda-
5 años en Cargill Iberia -España y Portugal: Responsable de avicultura y de aditivos
3 años Responsable de Monogástricos en Alltech Iberia -España y Portugal-

El objetivo de la conferencia es contar la experiencia (mi experiencia) con las recién registradas vacunas inactivadas de Kernfarm para Mycoplasma Synoviae y Mycoplasma gallisepticum.
Empezando por el proceso de registro en la AEMPS, donde hemos tenido que actualizar toda la información documental, consiguiendo el registro de la vacuna de MG en Enero de 2024 y de MS en Agosto 2024.
El proyecto de la incorporación de dos nuevas vacunas inactivadas para Mycoplasma (una para MG y otra para MS) nace de la necesidad en el mercado debido a las nuevas tendencias que venimos observando en los últimos años:
Incremento de sistemas alternativos.
Mayor longevidad de las gallinas.
Mayor coste de la pollita
Granjas multiedad.
Mayor recirculación de enfermedades. Mycoplasma abre el escudo inmunitario y es aprovechado por otras infecciones secundarias (ILT, IBV, Coli). Principalmente respiratorias, pero también intestinales.
Dificultad para aguantar calidad de cáscara en la última parte de ciclo productivo, que es donde tenemos la rentabilidad en un mercado como es el español de huevo grande.
Altas mortalidades acumuladas de enfermedades que antes pasaban más desapercibidas (Coli, ILT)


En España se vienen usando vacunas vivas para control de micoplasma aunque hay una tendencia cada vez mayor a combinarlas con vacunas inactivadas, hasta ahora (debido a que no había registro) fundamentalmente autovacunas. Por qué:
Actúan de modo diferente :
Vivas: inmunidad local desplazan la cepa campo.
Inactivadas: inmunidad humoral. Producen directamente anticuerpos.
Las vacunas inactivadas tienen una mayor duración de la inmunidad.
Aplicación y conservación suele ser más sencilla, aunque hemos comprobado que la ejecución de la vacunación es un tema fundamental.
La replicación de las vacunas de micoplasma es un tema controvertido, es difícil asociar anticuerpos con vacunación
Durante estos 2 años de camino también hemos realizado diferentes pruebas en clientes en España (unidas a las que hemos venido realizando en toda Europa) en clientes que venían usando vacunas vivas o que no utilizaban nada y hemos podido comparar diferentes resultados que mostraremos, donde lo más interesante ha sido comprobar:
Unos niveles de anticuerpos en sangre muy estables durante un periodo mucho más largo (incluso hasta matadero)
Unos resultados zootécnicos más estables, y sobre todo, con menos caídas de puesta o de calidad de cáscara en las últimas semanas del ciclo de la semana 60 a la 100).
Una menor utilización de antibióticos a los que antes teníamos que recurrir en muchas ocasiones, con la problemática que venimos arrastrando no solo para su utilización, sino también para la prescripción de los mismos.
Una menor mortalidad acumulada (-50% algunas veces) con un porcentaje de huevos rotos realmente muy mantenido.


BLOQUE 6 | Patología en avicultura de postura

Jueves 24 de octubre 2024
10:30 - 10:45
Jordi Serra Martínez*
*Estudio de la Dra. Kathrin Schulze Bernd


Jordi Serra Martínez
Sales Manager SANVET
Jordi Serra Martínez es un profesional en biotecnología con más de 20 años de experiencia en laboratorios de diagnóstico veterinario y producción biotecnológica.
Es licenciado en Biotecnología por la Universitat Autònoma de Barcelona y actualmente cursa un Máster en Dirección Comercial en EAE Business School (2023-2024). A lo largo de su carrera, ha ocupado puestos clave en importantes laboratorios de diagnóstico clínico veterinario, donde fue Director Técnico en todos ellos y copropietario en su última etapa como emprendedor.
Ha destacado en la gestión de equipos, optimización de procesos y la implementación de normativas GLP, GMP e ISO 9001 y 17025:2017. Jordi también posee un sólido dominio de inglés comercial y diversas herramientas como Microsoft Office, SAGE y sistemas CRM.

En cuanto a publicaciones, ha contribuido a la investigación sobre el uso de fluidos orales para la monitorización serológica de PRRSV, reflejando su enfoque en soluciones innovadoras para la salud animal.
Su experiencia incluye participación en simposios internacionales sobre diagnóstico veterinario y formación en el laboratorio de diagnóstico de la Universidad de Minnesota.
El virus de la bronquitis infecciosa (IBV) es un coronavirus aviar patógeno altamente contagioso que afecta principalmente a las aves de corral y puede causar problemas respiratorios, reproductivos y renales.
Se transmite a través de aerosoles, por contacto directo entre aves o por ingestión de alimentos, agua o heces contaminados. Los equipos y materiales contaminados también son una fuente potencial de transmisión indirecta a grandes distancias.
El virus de la bronquitis infecciosa es frecuente en todos los países con una industria avícola intensiva como por ejemplo, España.
Los síntomas incluyen:
Respiratorios: rinitis, secreción nasal, dificultad para respirar.
Reproductivos: disminución en la producción de huevos, huevos deformados, cáscara fina, menor incubabilidad.
Renales: excrementos húmedos “cama húmeda”
El diagnóstico es esencial para:
Monitoreo: mantener la salud del rebaño.
Problemas agudos y crónicos: identificar y manejar infecciones.
Vacunas específicas


1. PCR de cribado: Detecta todas las variantes de IBV.
2. PCR de variantes: Identifica variantes conocidas o indica la necesidad de secuenciación.
Secuenciación del gen S1: Clasificación de cepas en genotipos y linajes.
Es muy importante la secuenciación para detectar cepas recombinantes o nuevos genotipos que todavía no sé han caracterizado.
A partir de la secuenciación del gen S1, y basado en un estudio de Valastro et al. from 2016, diferenciamos los tipos de IBV entre linajes y genotipos. Para justificar un genotipo nuevo se requiere al menos un 30% de diferencia en el gen S1 completo. Para un linaje nuevo debe haber al menos un 15% de diferencia en el genoma.


CAVE: vaccination strains are included!

Aquí tenemos una descripción general de la distribución de las variantes de IBV detectadas por nosotros desde 2017 hasta 2023, dónde también aparecen las cepas vacunales. Se puede observar que las cepas vacunales son mayoritarias, aunque las cepas nuevas o emergentes toman relevancia.
Aproximadamente el 60% de las muestras positivas para ACoV fueron aptas para la secuenciación (CT <30)
Aproximadamente el 50% de estas fueron secuenciadas.

Variante 2: Encontrada en Alemania desde 2017.
D181: Detectada desde 2017 en Europa occidental y oriental
Cepas IB80: Detectada en 2015, asociada con pérdida de rendimiento en la puesta.
Aunque se han descrito otras nuevas cepas, la relevancia de estas está en proceso de estudio, es desconocida o no es importante, como por ejemplo la cepa V1397-like.
El IBV es un virus de alto impacto en la producción avícola, en especial en gallinas de puesta.
El diagnóstico es importante para obtener más información sobre la situación de campo y saber si es necesario un ajuste del programa de vacunación.
A menudo puede tener sentido realizar una secuenciación para ver si hay cepas recombinantes en el campo.
Al interpretar los resultados del diagnóstico, siempre debe tener en cuenta la situación clínica y el programa de vacunación.
Monitoreo: Nos permitirá en todo momento conocer el estado de las aves y tomar medidas en función de este.
Vacunas comerciales: Disponibles para diferentes cepas de IBV (vacunas vivas atenuadas, inactivadas, monovacunas o en combinación con otros patógenos)
Autovacunas: Necesarias cuando no hay una vacuna comercial disponible. Han demostrado su eficacia en varios países de Europa.











Pablo Soler Romero
Pablo Soler Romero
Servicios Técnicos Avicultura España Calier
Licenciado en Veterinaria en 2011 por la Universidad Cardenal Herrera CEU de Valencia, Pablo Soler ha trabajado en el sector avícola durante más de una década.
Entre 2012 y 2021, desempeñó funciones como veterinario de campo en Grupo SADA, primero como responsable técnico en explotaciones de broilers y luego en explotaciones de reproductoras pesadas, tanto de recría como de puesta, en las regiones de la Comunidad Valenciana, Aragón y Cataluña.
Desde septiembre de 2021 hasta septiembre de 2023, formó parte del equipo técnico veterinario de Avigan Terralta, donde se encargó de la venta de pollitas de día y recriadas, además de proporcionar servicios técnicos a los clientes. Durante este periodo, también asumió responsabilidades de coordinación y gestión de las recrías de pollitas comerciales de la empresa.

En octubre de 2023, inició una nueva etapa en Laboratorios Calier, trabajando en la línea de avicultura como técnico. En este rol, brinda servicios a clientes de toda España, enfocándose principalmente en la realización de auditorías, mejoras en los programas de vacunación en explotaciones, toma de muestras y asesoramiento técnico sobre los productos y servicios que ofrece el laboratorio.
La salmonelosis es una patología del hombre y de los animales causada por microrganismos del género Salmonella, ampliamente conocido en nuestro sector y que sigue teniendo actualmente un fuerte impacto socioeconómico.
Salmonella afecta a las producciones avícolas por diversos motivos, como son:
3 4 1
Importancia en Salud Pública: es una zoonosis de primer orden.
2
Importancia en Salud Animal: este punto no es aplicable en España, sin embrago, en otras naciones Salmonella Gallinarum puede provocar patología de carácter grave en granjas avícolas, con la consecuente pérdida económica y afectando al bienestar animal.
Importancia en el Comercio Internacional: las compañías que se dedican a la comercialización de productos avícolas a nivel internacional, pueden perder mercados debido a la contaminación de lotes ya que dicha comercialización puede quedar impedida o restringida con países terceros.
Importancia en la Marca: la publicidad negativa siempre ha tenido un impacto muy dañino para las marcas comercializadoras de productos del sector primario, pero la época actual su repercusión se ha multiplicado por la generalización de la difusión de los medios de comunicación y la capacidad del público general de convertirse en “creadores de contenido y opinadores” (ej: redes sociales, reseñas de producto, marca y establecimientos…)

¿Por qué vacunar
Centrándonos en el primer punto, la salmonelosis sigue siendo la segunda causa de toxinfecciones a nivel europeo, solo por detrás de Campylobacter. Los serotipos aislados de forma mayoritaria en casos de medicina humana son Salmonella Enteritidis y Salmonella Typhimurium (datos EFSA).
Existe una relación entre los principales serovares de Salmonella con su origen productivo (pollos, ponedoras, pavos, cerdos y bovinos).
Tanto Salmonella Enteritidis como Typhimurium están íntimamente relacionadas con la producción de carne de pollo como con la de huevos para consumo.
Debido a estos argumentos, se instauraron en los países miembros de la UE los Programas Nacionales de Control de Salmonella (PNCS).
En el caso de ponedoras el PNCS establece que las gallinas “se someterán al menos durante la fase de cría, a programas de vacunación obligatorios contra Salmonella Enteritidis que reduzcan la excreción y la contaminación de los huevos”.

En la siguiente gráfica, se muestra cómo se redujo en el caso de ponedoras los lotes positivos en controles oficiales desde el 15.60% en 2008 al 1.62% en 2022 (PNCS 2024).

Según PNCS ponedoras con datos 2022, Salmonella Enteritidis sigue siendo el serotipo mayoritario en granjas de puesta, con el 15.13% de los aislados.
A
la vista de estos datos, se puede afirmar que las estrategias determinadas en los PNCS han sido exitosas a la hora de reducir el % de lotes positivos, entre ellas la vacunación en recría.


Pero entonces, ¿por qué deberíamos vacunar de Salmonella Enteritidis durante el periodo de puesta?
Por tres motivos:
Primer motivo
El primero lo acabamos de ver: porque sigue siendo necesario, por salud pública.
Salmonella Enteritidis sigue siendo el serovar dominante tanto en los aislados de salmonelosis en humanos cómo en los lotes positivos de granjas de puesta comerciales.
Segundo motivo
El segundo es la correlación que existe entre la edad de los lotes y el aumento de positividad de los mismos.
Los lotes positivos se concentran en la segunda mitad del ciclo productivo.
Podéis observar cómo a partir de la semana 50 de vida hay un mayor riesgo de contaminación del lote, por lo que podemos pensar que existe un “GAP “inmunitario a partir de estas edades que impide afrontar de forma eficaz los desafíos con cepas de campo que puedan producirse, solo con las vacunas administradas en recría.
Positivos a Salmonellas zoonóticas en ponedoras (2022)
% Prevalencia 2022 Ponedoras España: 1,62%
Fuente: CESAC.
Porcentaje positivos según edad (ponedoras 2022)



¿Por
Positivos a Salmonellas zoonóticas en ponedoras (2023)

Porcentaje positivos según edad (ponedoras 2023)



Tercer motivo
El tercer motivo, es que los ciclos productivos son cada vez más largos.
Es ampliamente conocido que las gallinas cada vez producen más, con mejor calidad de cáscara y durante más tiempo.
Esto es debido tanto a lo que puede aportar las propias mejoras en genética, como en manejo y nutrición.
Actualmente, es relativamente común alcanzar duraciones de ciclo de puesta de ponedoras Brown de entre 90- 95 semanas.
Por ello, el peso y la importancia de la “última etapa del lote” en relación al total, cada vez es más importante.
Por tanto, la vacunación de Salmonella Enteritidis en puesta es una herramienta útil para combatir estos tres puntos críticos:
1. Salmonella Enteritidis está fuertemente unida a las toxinfecciones y a las granjas de puesta
2. A más edad de los lotes, más lotes positivos.
3. Los lotes cada vez tienen ciclos productivos más largos.
¿Por
Una vez dicho esto, ¿qué características le debemos pedir a una vacuna frente a Salmonella
Enteritidis en puesta?.
Le debemos pedir que cumpla con estos cuatro puntos:
Que sea segura: es decir, que la cepa vacunal no se excrete una vez se haya aplicado la dosis en puesta, con el fin de evitar que dicha cepa vacunal pueda llegar al consumidor final. En el estudio realizado para su registro, se pudo demostrar que su excreción era cero tras recoger 730 muestras (245 hisopos cloacales, 73 en órganos y 412 en huevos).
Además, que no afecte a la puesta. Se demostró que no había diferencias significativas entre la producción del grupo vacunado sólo con las tres dosis de recría en comparación al grupo vacunado con las tres dosis en recría y la cuarta en puesta.
Que sea de fácil aplicación: se trata de una vacuna viva que se aplica en el agua de bebida, facilitando enormemente la logística de vacunación de los lotes.
Que sea eficaz: es decir, que pueda reducir la excreción de las cepas de campo ante posibles desafíos y que alargue la inmunidad del lote. De esta forma, cubrimos de forma satisfactoria esa última etapa del lote y neutralizamos ese GAP inmunitario no cubierto por las vacunas aplicadas en recría.
Con una buena relación gasto económico y resultado: la guerra contra la salmonella se debe librar atacando por diversos frentes, como son la bioseguridad, uso de aditivos preventivos en el pienso, higiene del agua, y la vacunación. Estos “frentes” no deben ser excluyentes, si no que deben plantearse como una estrategia completa. 1 2 3
Tenemos muy asumido que para luchar en contra de las salmonellas de campo, es vital una buena bioseguridad como el uso de ciertos aditivos, por lo que usamos estas armas de forma rutinaria.
Dentro del coste total de la prevención frente a Salmonella, la vacunación es la que menos porcentaje de gastos ocupa dentro de la ecuación.
Si pensamos en el total del coste de la lucha frente a Salmonella (durante el ciclo de puesta), los aditivos en el pienso y agua ocuparían el 55%, la bioseguridad (L+D+D) un 35%, y la vacunación con una dosis frente a Salmonella Enteritidis solamente el 10%. Además, en algunas CC.AA. ésta cuarta dosis está subvencionada.
La vacunación es un arma directa frente a Salmonella, ya que estamos introduciendo una cepa viva atenuada para que compita con las cepas de campo y a la vez inmunice a la gallina. Es un arma con efecto directo en contra de la Salmonella Enteritidis y con un coste relativamente bajo.
Por lo tanto, la vacunación en puesta frente a Salmonella Enteritidis es un arma segura, eficaz, de fácil aplicación y con una buena relación coste económico/resultado que ayuda a minimizar los riesgos de contaminación de los lotes cuando más es necesario (al final de los ciclos productivos) reforzando la inmunidad de nuestras gallinas.
aviforum.info
157
¿Por qué vacunar frente a Salmonella Enteritidis durante la puesta?

La primera y única vacuna viva bivalente contra la Salmonella

El código QR corresponde al SPC. En caso de duda consulte a su veterinario. PM-ES-22-0238. © 2023 Elanco Animal Health, Inc. o sus afiliadas. Avipro, Elanco y la barra diagonal son marcas registradas de Elanco o sus filiales, Elanco Spain S.L.U. Av.de Bruselas, 13-2ºA 28108 Alcobendas (Madrid) www.elanco.es


Félix Ponsa
Technical Consultant de avicultura en Elanco Iberia
Licenciado en veterinaria en la Facultad de Zaragoza en la especialidad de producción animal y economía.
Estuvo 18 años en el CESAC como responsable del departamento de patología y parasitología aviar.
Es experto en prevención y sanidad avícola y en el control de las zoonosis transmitidas por los alimentos como Salmonella y Campylobacter.

En 2008 se incorporó a Lohmann Animal Health España como técnico veterinario avícola y en 2012 fue nombrado Global Technical Support Manager para vacunas aviares en el departamento de marketing internacional.
Desde el 1 de noviembre de 2014 es Technical Consultant de avicultura en Elanco Iberia sobre temas de integridad intestinal y seguridad alimentaria.
Cuando hablamos de Salmonella en avicultura debemos diferenciar dos grupos:
Salmonelas tíficas (S. Pullorum y S. Gallinarum), inmóviles, sin flagelos, específicas aviares, que dan lugar a mortalidad y enfermedades septicémicas agudas como la Pullorosis y la Tifosis aviar, erradicadas hoy en la industria avícola española.
Salmonelas paratíficas (> 2.500 serotipos), móviles, con flagelos, inespecíficas, que pueden afectar a diferentes especies sin causar en enfermedad (portadores asintomáticos) y son zoonóticas causantes de toxiinfecciones alimentarias en seres humanos.
S. Enteritidis y S. Typhimurium (incluida la variante monofásica) son los principales serotipos de este último grupo y constituyen el objetivo de control en el Plan Nacional de Control de Salmonella en el sector avícola de puesta.
Desde el año 2008, tras la implantación de la vacunación contra S. Enteritidis y los Planes Nacionales de Control de Salmonella en la Unión Europea, después de más de quince años de vigilancia activa en las granjas de gallinas ponedoras, y a pesar de los logros conseguidos en el sector avícola español al cumplir los objetivos de reducción de prevalencia establecidos (2%), la salmonelosis sigue siendo una de las principales toxiinfecciones alimentarias en los seres humanos.
De los casos declarados de salmonelosis en humanos adquiridos en la UE en 2022, el 84,7% de los casos fueron por S. Enteritidis y S. Typhimurium (incluida la monofásica).
Así pues, una vacuna viva que contenga los serotipos homólogos de S. Enteritidis y S. Typhimurium proporcionará la mayor cobertura de protección a las aves para proteger a los seres humanos.
El objetivo de la vacunación de las gallinas ponedoras es la seguridad alimentaria. Protegiendo a las gallinas, protegemos al consumidor.
Actualmente, en el sector avícola de puesta es motivo de preocupación la prevalencia de S. Typhimurium en el sector porcino, en el cual aún no se han implantado los programas nacionales de control, y el aumento de la prevalencia de S. Infantis en las granjas de pollos de engorde.
La proximidad de granjas de cerdos y pollos con animales que pueden ser portadores asintomáticos y la gestión de los purines y la gallinaza que pueden estar contaminados suponen una amenaza constante para los núcleos avícolas de puesta en los que hay que adoptar las máximas medidas de bioseguridad y prevención.
patrón de resistencia a un número amplio de antibióticos similar al de otras cepas de S. Typhimurium, es un problema emergente y centra la atención de las autoridades sanitarias.
Los sistemas de producción extensivos al aire libre de gallinas camperas y ecológicas tienen alto riesgo de contaminación, debido a las limitadas medidas de bioseguridad. En estos casos es altamente recomendable el uso de la vacuna viva bivalente para proporcionar la máxima cobertura de protección contra S. Enteritidis y S. Typhimurium.
La legislación europea actual prohíbe el uso preventivo de los antibióticos para el control de Salmonella debido a los riesgos de salud pública asociados al desarrollo y diseminación de aislados de Salmonella multiresistentes a los antibióticos y promueve el uso prudente en caso necesario.
Por consiguiente, la vacunación con cepas vivas atenuadas con un periodo limitado de excreción se convierte en una técnica clave para el control de Salmonella en avicultura.
Las experiencias de los últimos quince años revelan que las vacunas de salmonela administradas a gallinas futuras ponedoras y futuras reproductoras han demostrado un buen perfil de seguridad y han jugado un papel muy importante en la prevención de las infecciones causadas por S. Enteritidis, tanto en las manadas avícolas como en los seres humanos, y han contribuido de una forma determinante en la consecución de los objetivos de reducción de prevalencia de Salmonella establecidos en la Unión Europea.
Edad de la primera vacunación
Método de administración
Inicio de la inmunidad
Se pueden usar de forma segura desde el primer día de vida. No hay vacío de protección.
En el agua de bebida, en gel o en spray gota gruesa.
En las pocas horas después de la vacunación por medio de mecanisoms no espcíficos (exclusión competitiva).
Inmunización activa a partir de 14 días.
Eficacia 1. Exclusión competitiva - Inhibición de la colonización.
2. Inmunidad celular (macrófagos, heterófilos, linfocitos, etc.).
3. Inmunidad humoral local (IgA secretora)
(las cepas de Salmonella de campo se pueden detectar y combatir antes de entrar en la mucosa intestinal y llegar a la corriente sanguínea).
Protección cruzada Niveles específicos e inespecíficos de inmunidad cruzada probados.
Interferencia de los autocontroles
Mínima y transitoria interferencia de los controles serológicos.
Fiable diferenciación de cepas vacunales y de campo usando métodos bacteriológicos y PCR.

Normalmente se usan a partir de las 6-8 semanas de vida. Revacunación semanas después. Vacío de protección inicial.
Inyección subcutánea o intramuscular (reacciones vacunales dolorosas)
Inmunidad fiable después de una segunda vacunación.
1. Inmunidad humoral sistémica. Producción de niveles altos de IgM e IgG de larga duración en sangre (las cepas de Salmonella se campo solo se pueden detectar y combatir después de entrar en la mucosa intestinal y llegar a a corriente sanguínea).
Más limitada.
Larga interferencia de los controles serológicos (ELISA, ARP).
No intefiere los autocontroles microbiológicos.

Los estudios demuestran que la elección estratégica de una vacuna viva bivalente con cepas homólogas contra S. Enteritidis y S. Typhimurium potencia la inmunidad específica contra las cepas de campo de S. Enteritidis, S. Typhimurium y ST monofásica hasta el final del ciclo de producción.
En 2010, Desloges et al., demostraron que la vacuna viva bivalente tiene un buen perfil de seguridad y eficacia después de un desafío con altas dosis tanto de S. Enteritidis como de S. Typhimurium, los dos serotipos más prevalentes en avicultura. Por otro lado, en 2015, Kilroy et al., demostraron que también es eficaz contra S. Typhimuriun monofásica.
En 2017, Van Immerseel et al., demostraron que la vacuna viva bivalente también proporciona protección contra la colonización de órganos internos y ciegos de S. Infantis. Este tipo de protección cruzada contra serotipos heterólogos emergentes es importante porque indica que la protección de las ponedoras y reproductoras puede ser bastante más amplia que de serotipo específico, lo que es importante para el control general de Salmonella


El control de las salmonelas en las aves de producción se fundamenta en las medidas de bioseguridad, las buenas prácticas de manejo, altas exigencias de higiene y desinfección, la implantación de autocontroles y la vacunación.
Las experiencias de estos últimos quince años demuestran que las vacunas para las gallinas ponedoras y reproductoras han sido un elemento clave en la prevención de las infecciones causadas por Salmonella
Las vacunas tienen que ir asociadas a un control integral de Salmonella. Sólo una combinación de altos estándares en bioseguridad, higiene, desinfección y control de vectores, así como una vacunación adecuada con vacunas vivas homólogas, puede proteger a las aves contra las infecciones por S. Enteritidis y S. Typhimurium de una forma sostenible.
La vacuna viva bivalente es altamente recomendable en los sistemas de producción extensivos de gallinas camperas y ecológicas que tienen un alto riesgo de contaminación, debido a las limitadas medidas de bioseguridad.
REFERENCIAS DISPONIBLES BAJO PETICIÓN
EM-ES-24-0101

Ana Fernández, DVM PhD

Ana Fernández, DVM PhD
Responsable del Departamento de Autovacunas del Laboratorio veterinario Exopol
Veterinaria licenciada en 1994 por la Universidad de Zaragoza.
Doctorado en 1999 por la Universidad de Zaragoza. Su investigación sobre enfermedades infecciosas, epidemiología e inmunología le permitió formarse en las distintas técnicas laboratoriales y en el diseño de estudios.
Desde 1999 trabaja en Exopol, laboratorio de diagnóstico veterinario y producción de autovacunas, donde en un principio se dedicó al diagnóstico de enfermedades infecciosas para posteriormente pasar al departamento de I+D y finalmente al de Autovacunas.
Desde 2009 es la responsable del Departamento de Autovacunas en esta empresa donde ha desarrollado nuevos productos para diversas especies animales ganaderas y donde se dedica a la mejora continua de los mismos.

Ha sido profesora asociada en la Universidad de Zaragoza, participa en proyectos de investigación y es autora o coautora de artículos científicos, divulgativos y comunicaciones a congresos. Contribuye también a la formación de posgrado de graduados que desarrollan su actividad laboral en Exopol, dirigiendo Tesis doctorales o Trabajos de Fin de Master.
Las autovacunas son herramientas de prevención complementarias a las vacunas registradas que nos ayudan en el control de las enfermedades infecciosas. En los últimos años en los que desde una perspectiva One Health han aparecido nuevas regulaciones que limitan el uso de antimicrobianos, no cabe duda de que herramientas preventivas como estas han adquirido una importancia más relevante.
El uso y producción de autovacunas en veterinaria estaba regulada en nuestro país desde 1995 (RD 109/1995), pero la publicación del Reglamento Europeo 2019/6 sobre medicamentos veterinarios que entró en vigor en 2022, unifica la normativa para todos los estados miembros y de ello se ha derivado la publicación del nuevo Real Decreto 666/2023.
En base a esta normativa, una autovacuna de uso veterinario es un “Medicamento inmunológico inactivado que se elabora a partir de microorganismos patógenos y antígenos obtenidos de material biológico de uno o varios animales de una unidad epidemiológica y con destino a los animales de esa unidad, o de otra con la que se haya establecido una relación epidemiológica confirmada”
No está claramente establecido qué se entiende por unidad epidemiológica, pero a efectos prácticos podemos considerar que una explotación ganadera conforma una unidad, estando sus animales expuestos a los mismos patógenos con la misma probabilidad.
En el RD 666/2023, sin embargo, sí que se especifica la relación epidemiológica, y se puede concluir que es aplicable a aves cuando se consideran líneas parentales criadas en sistemas de cadena de producción.
Con el nuevo RD, ya es posible fabricar en España autovacunas víricas y hacer una misma autovacuna para más de una granja, aspectos limitados en la anterior legislación nacional, ya derogada.


Las principales características de las autovacunas es que son vacunas muy específicas y siempre inactivadas.
Se elaboran con los patógenos propios de la granja o grupo de granjas relacionadas para las que va destinada.
Se producen bajo demanda, no son productos industriales, y esto las hace también muy versátiles, siendo posible incluir varios agentes o variantes antigénicas en una misma autovacuna y actualizarlas con nuevos patógenos siempre que sea necesario.
¿Cuándo
Son complementarias a las vacunas registradas y pueden usarse en los siguientes supuestos:
Si no existe una vacuna comercializada para esa especie animal y esa indicación (o las existentes no están disponibles). Algunos ejemplos en especies avícolas de producción serían las autovacunas frente a Pasteurella multocida, Ornithobacterium rhinotracheale, Riemerella anatipestifer, Erysipelothrix rhusiopathiae, Gallibacterium anatis, Staphylococcus sp., Enterococcus sp., Adenovirus tipo I, Reovirus, etc.
Cuando las vacunas registradas no incluyen las variantes antigénicas de nuestra granja y no se da inmunidad cruzada entre ellas. En ese caso se requiere la caracterización antigénica por técnicas laboratoriales.
Si existe vacuna comercial idónea, puede justificarse el uso excepcional de una autovacuna en caso de falta de eficacia probada y habiendo sido esta comunicada al Sistema Español de Farmacovigilancia Veterinaria.


¿Cómo es el proceso desde la obtención de cepas hasta la aplicación en granja?
La primera vez que se plantea su uso en una granja debemos seguir los siguientes pasos:
1. Toma de muestras por parte del veterinario ante la presencia de un proceso patológico en la granja y envío al laboratorio.
2. Diagnóstico laboratorial. El laboratorio hará un diferencial completo, identificará el patógeno (uno o varios), obtendrá las cepas en cultivo y las caracterizará antigénicamente.
3. Diseño de la autovacuna. Se determina la composición que debe incluir entre el veterinario y el productor de la autovacuna.
4. Orden de pedido. Se hace mediante la firma de una prescripción veterinaria (excepcional).
5. Fabricación. Solo en laboratorios productores autorizados, que siguen sus protocolos estandarizados de producción y de control de calidad. El tiempo necesario de producción variará según los patógenos incluidos, pero se estima entre 4 y 8 semanas.
6. Envío, siempre directo a granja, propietario o veterinario.





es la composición antigénica. Por ello es importante hacer un abordaje diagnóstico adecuado a nuestro objetivo.
Dependiendo de la patología se orientará el tipo y número de muestras a tomar, para lo que habitualmente son necesarios varios muestreos.
También el tipo de diagnóstico laboratorial a realizar vendrá determinado por nuestro objetivo.
Es aquí donde en los últimos años se han hecho importantes avances que nos permiten seleccionar las cepas más idóneas a incluir para que las probabilidades de éxito sean máximas.
Nos basamos en tecnología MALDI-TOF MS para la identificación bacteriana y en diversas técnicas moleculares que nos ayudan en la caracterización de las variantes antigénicas.
Por poner algunos ejemplos, se utiliza rutinariamente la secuenciación parcial para identificar serotipos de Adenovirus tipo I, variantes del virus de la bronquitis aviar o serotipos y subtipos de A. paragallinarum. Para variantes de O. rinotracheale nos podemos ayudar de la técnica MLST. En P. multocida se determina el tipo capsular y LPS mediante qPCR y las cepas de E. coli se pueden caracterizar en base a su serotipo y a su patrón de entre 8 y 12 factores de virulencia mediante qPCR. El futuro próximo pasa por la secuenciación genética completa de los microorganismos (WGS).
La firma de la prescripción excepcional permite iniciar la fabricación de las dosis solicitadas.
El veterinario podrá volver a prescribir la producción de nuevos lotes de autovacuna con esa composición para las granjas epidemiológicamente relacionadas sin repetir todo el proceso de muestreo, tantas veces como quiera mientras su uso esté justificado.
La justificación de este uso puede basarse en resultados laboratoriales que confirman la presencia del patógeno a lo largo del tiempo y/o en el conocimiento epidemiológico de la explotación por parte del veterinario. Se recomienda por ello realizar muestreos al menos de forma bianual.
La posibilidad de actualizar la composición antigénica siempre que sea necesario es una de las grandes ventajas de las autovacunas. Para ello es fundamental hacer un trabajo constante de diagnóstico y mantenimiento de un cepario para cada caso.
Los otros dos puntos clave en el éxito de una autovacuna radican en la calidad de la fabricación, que dependerá de cada fabricante, y en el correcto protocolo de aplicación en granja.
Podemos decir que las autovacunas son una herramienta más con la que podemos contar para la prevención de procesos infecciosos en avicultura, lo que nos ayuda también a reducir el uso de antimicrobianos.
Pero es importante que siempre se prescriban tras un correcto y preciso diagnóstico, se fabriquen en un productor autorizado y de confianza y se apliquen adecuadamente en granja siguiendo un programa de control previamente establecido.
aviforum.info
la respuesta eficaz y sostenible a los problemas provocados por micoplasma

Aivlosin 625 mg/g Granulado para administración en agua de bebida. Principio activo: Tilvalosina tartrato 625 mg/g Forma Farmaceútica Granulado para administración en agua de bebida Especies: Pollos. Tratamiento y prevención de infecciones respiratorias asociadas con Micoplasma gallisepticum. Pavos: Tratamiento de afecciones respiratorias asociadas con cepas de Ornithobacterium rhinotracheale La estrategia de prevención deberá incluir todas las medidas para eliminar la infección de la generación de los progenitores. Contraindicaciones: Ninguna. Reacciones adversas: Ninguna conocida. Interacción con otros medicamentos y otras formas de interacción: Ninguna conocida. Posología y forma de administración: Para administración en agua de bebida. Para el tratamiento de afecciones respiratorias asociadas con Micoplasma gallisepticum La dosis diaria es de 25 mg de tilvalosina por kg de peso vivo diluidos en el agua de bebida durante 3 días consecutivos. Pavos :Para el tratamiento de afecciones respiratorias asociadas con Ornithobacterium rhinotracheale: La dosis diaria es de 25 mg de tilvalosina por kg de peso vivo diluidos en el agua de bebida durante 5 días consecutivos. Sobredosificación: No se han observado signos de intolerancia en los pollos a los que se les ha administrado hasta 150 mg de tilvalosina diarios por



Claudio Chimienti DMV


Claudio Chimienti DMV VET&SPHERE Reseau Cristal Francia
Actualmente Claudio Chimienti es socio mayoritario en el grupo veterinario VET&SPHERE, donde trabaja como veterinario avícola en Bretaña. La estructura VET&SPHERE, compuesta por unos 35 veterinarios, cubre la mayoría de los campos de la medicina veterinaria excepto la acuicultura.
Además de su actividad de campo, en broilers, layers y reproductoras en las especies gallus, pavos y patos, Claudio Chimienti realiza una actividad como consultor para varias empresas mayores de la industria avícola (farmacéuticas, nutricionistas y genéticas) en temas de calidad de productos, bioseguridad o reducción del uso de antibióticos, en Europa, Asia, LATAM, Medio Oriente y África del Norte.

La industria avícola de puesta en Europa enfrenta hoy un reto de gran envergadura a nivel mundial, no solo en términos de volumen de producción, sino sobre todo en la calidad. Las transformaciones del mercado en la última década han generado cambios estructurales significativos, destacando que, para 2024, más del 60% de las gallinas ponedoras europeas estarán alojadas en sistemas alternativos a las jaulas enriquecidas.
Estos cambios responden tanto a la demanda de los consumidores como a las disposiciones legislativas, aunque su implementación se ha visto ralentizada por las sucesivas crisis económicas (COVID-19, gripe aviar, y el aumento del coste energético derivado de la guerra en Ucrania).
Las dudas sobre la viabilidad y sostenibilidad del Pacto Verde europeo generan serios debates entre la industria, los políticos y los consumidores.
La necesidad de una producción eficiente y sostenible en Europa es incuestionable, impulsada por la importancia de garantizar la soberanía alimentaria y la seguridad alimentaria.
Durante mucho tiempo, el uso de antibióticos en la avicultura de puesta fue una solución fácil para compensar errores productivos o nutricionales. Esos usos sin justificación no son actualmente aceptables, pero las exigencias
productivas y la fisiopatología respiratoria de las aves hace necesario en algunos casos el uso de antibióticos eficientes.
Uso

La elección del producto adecuado es compleja, ya que, además de factores tradicionales como la biodisponibilidad, la eficacia y el costo directo, ahora deben considerarse aspectos como el impacto ambiental del producto y su huella de carbono.
Un buen diagnóstico es esencial
antes
de iniciar
cualquier tratamiento, y para lograrlo, es indispensable realizar un muestreo adecuado que permita identificar con precisión
el patógeno, evitando errores analíticos que puedan distorsionar los resultados del laboratorio.
Una vez confirmado el diagnóstico, es crucial determinar si los animales están o no enfermos, en línea con los requisitos europeos sobre el uso de antibióticos en casos de metafilaxis.
Al definir la enfermedad, debemos considerar tanto los aspectos económicos como los medioambientales, ya que existe una marcada dicotomía entre los costos fijos y variables.
Los costos fijos, como la pérdida de producción, están bien identificados desde una perspectiva económica.
Sin embargo, el costo ambiental sigue siendo un área poco comprendida, especialmente en lo que respecta al impacto “carbono” asociado a la sustitución de animales muertos.
Al elegir el antibiótico adecuado, el veterinario debe considerar todos estos factores, y recordar que, muchas veces, lo barato puede salir caro.

aviforum.info
